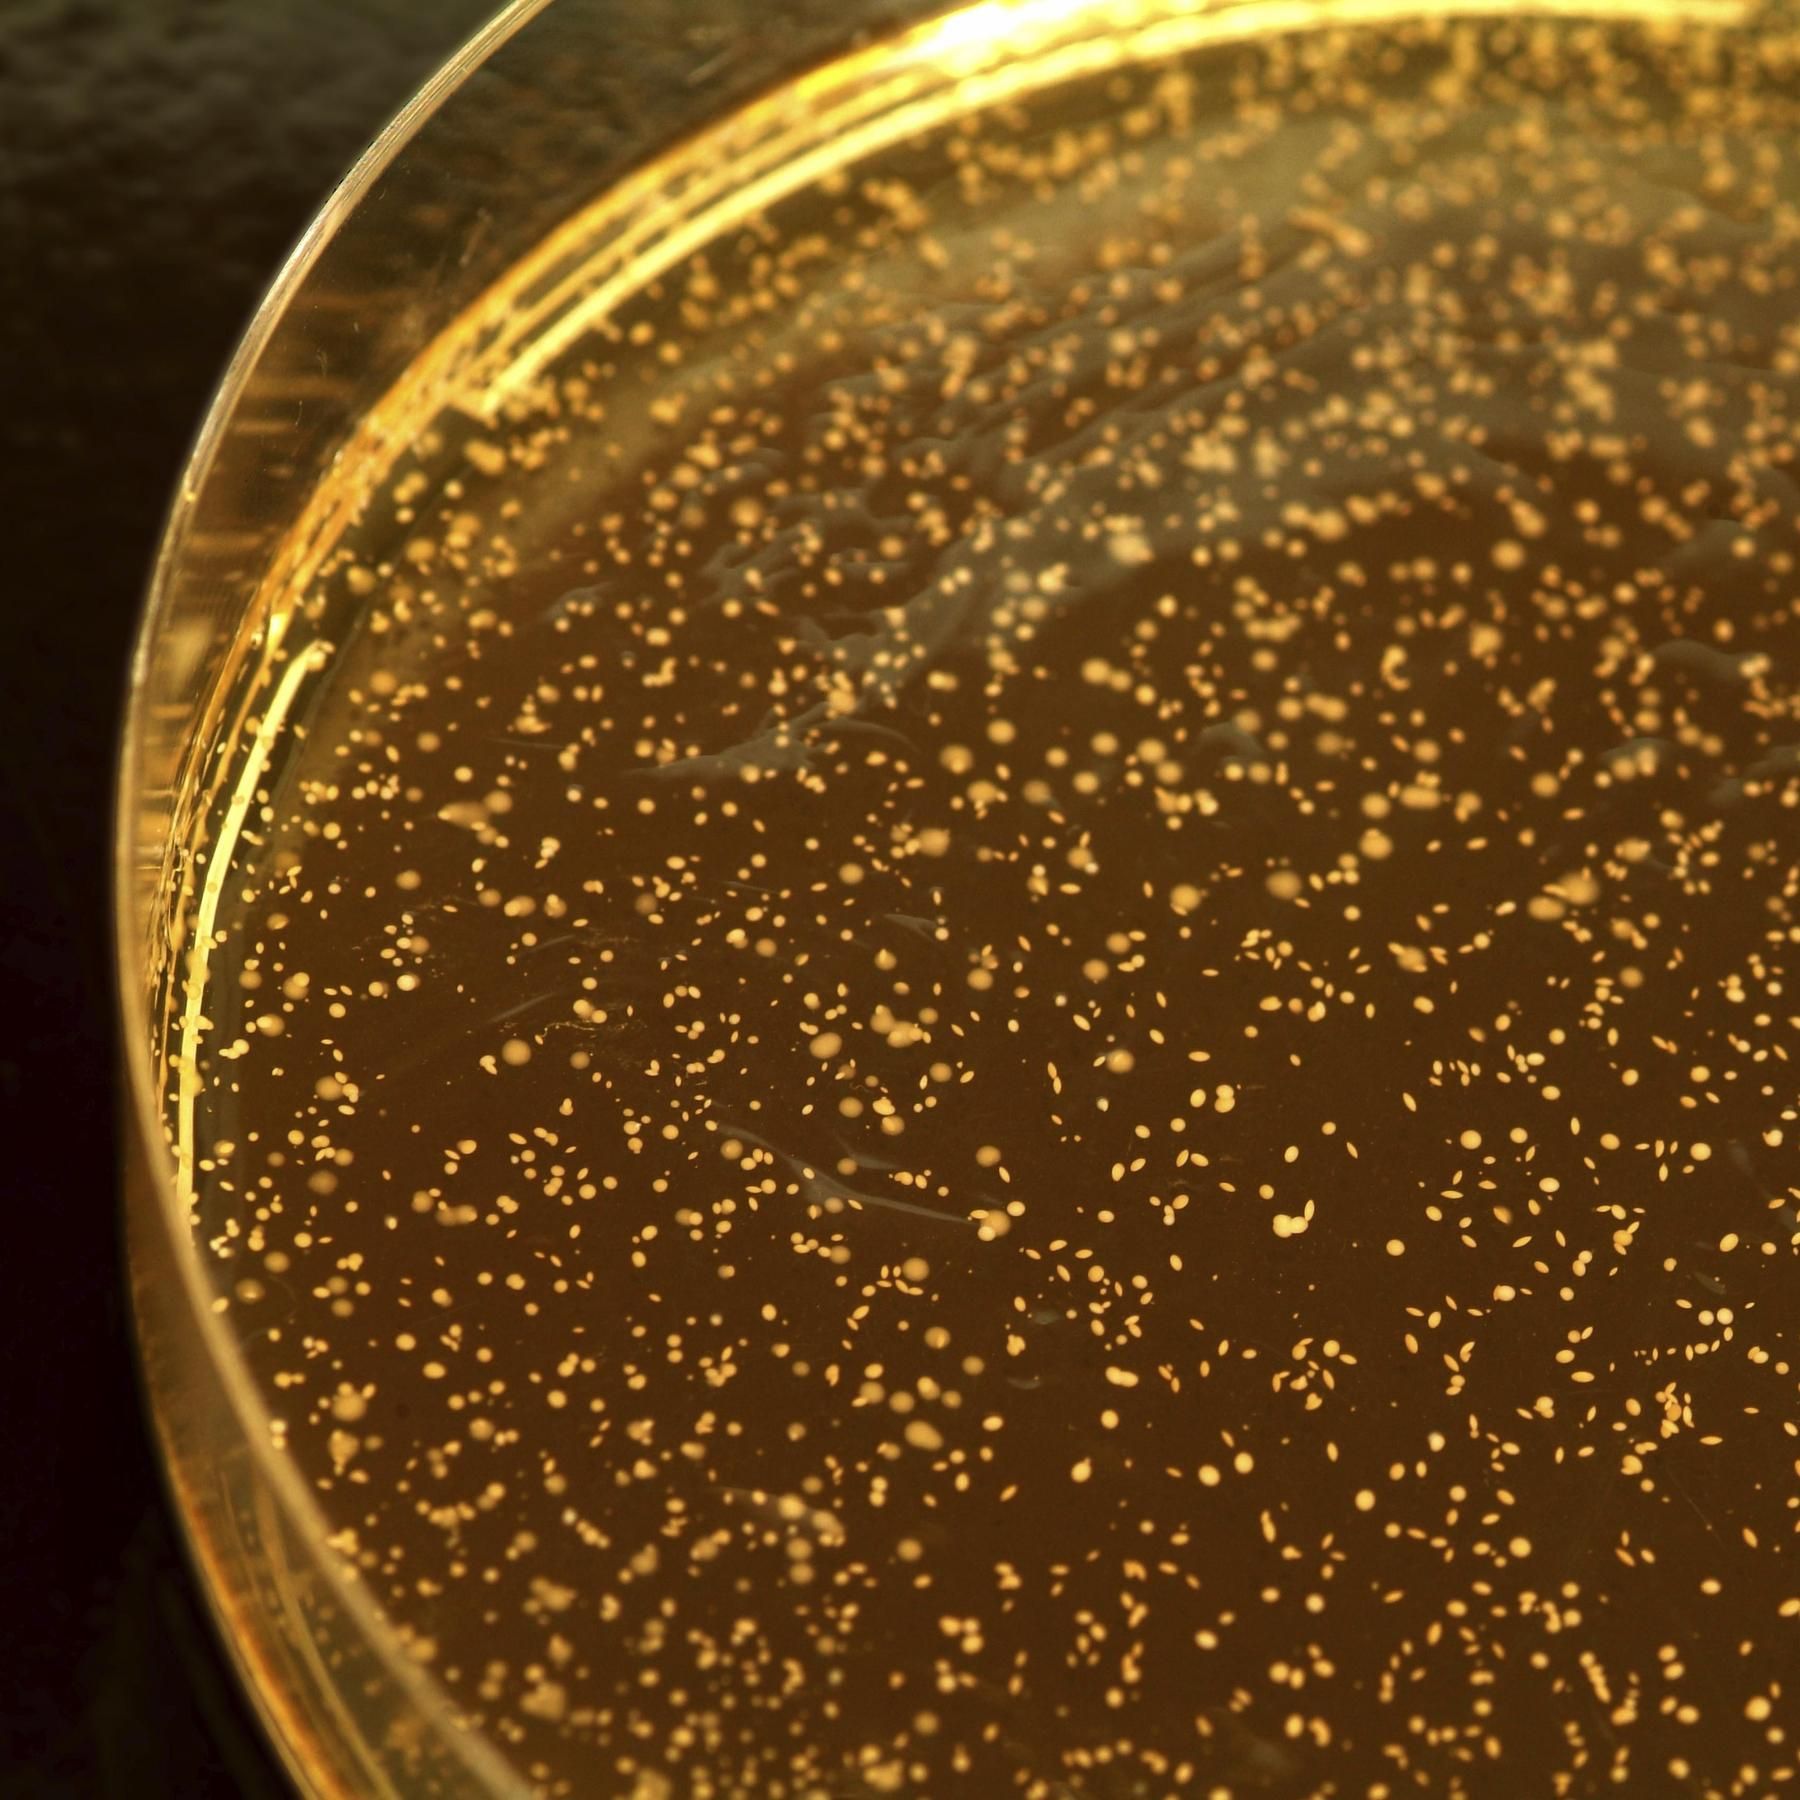

Wenig Zeit, trotzdem neugierig? "IQ - Wissenschaft schnell erzählt" ist Euer Podcast Update für alles, was Ihr zu aktueller Forschung wissen müsst. Kurz, relevant und überraschend. Weil Wissenschaft unser Leben bis in den letzten Winkel prägt. Wir sind die Wissenschaftsjournalisten des Bayerischen Rundfunks und wollen mit Euch den Überblick behalten. Über Themen aus Gesundheit, Technik, Natur und Umwelt. Von neuen Medikamenten bis zu künstlicher Intelligenz, von Vulkanen bis zu den erstaunlichen Fähigkeiten der Tiere, von neuen High-Tech Ideen bis zu den schönsten Dingen am Sternenhimmel. Wir erzählen die wichtigsten, spannendsten und skurrilsten Geschichten aus der Forschung - damit Ihr sie weitererzählen könnt.
Alle Folgen
Demenz durch Luftverschmutzung - So groß ist das Risiko | Tiefsee - Unerwartetes Leben entdeckt
Wenig Zeit - trotzdem neugierig? Hier ist Euer Podcast Update für alles, was Ihr zu aktueller Forschung wissen müsst. Kurz, relevant und überraschend. Die Themen in dieser Podcast-Folge: (00:00:36) Demenz durch Luftverschmutzung - So groß ist das Risiko | https://www.thelancet.com/journals/lanplh/article/PIIS2542-5196(25)00118-4/fulltext (00:03:09) Unerwartete Entdeckung - Höheres Leben in der Tiefsee entdeckt https://press.springernature.com/flourishing-chemosynthetic-life-at-the-greatest-depths-of-hadal-/51209352 (mit Bildern und Videos) CREDITS Host der heutigen Folge ist Stefan Geier. Die Geschichten hat Hellmuth Nordwig recherchiert Wir freuen uns über Post von Euch: WhatsApp (https://wa.me/491746744240) oder iq@br.de Immer noch neugierig - und mehr Zeit? Dann empfehlen wir Euch unseren IQ Podcast, der in die Tiefe geht: IQ - Wissenschaft und Forschung Alle Folgen gibt es z.B. in der ARD Audiothek https://1.ard.de/IQWissenschaft

Immunsystem - So springt es richtig an | Ameisen- fressen - Lohnt sich offenbar mehrfach | Ameisenbär
Wenig Zeit - trotzdem neugierig? Hier ist Euer Podcast Update für alles, was Ihr zu aktueller Forschung wissen müsst. Kurz, relevant und überraschend. Die Themen in dieser Podcast-Folge: (00:00:36) Immunsystem - So springt es richtig an - Früh genug nur beim Zuschauen https://www.nature.com/articles/s41593-025-02008-y | (00:03:09) Ameisen- fressen - Lohnt sich offenbar mehrfach - Der Ameisenbär ist in der Evolution "mehrfach entstanden" https://www.science.org/content/article/things-keep-evolving-anteaters-odd-animals-arose-least-12-separate-times https://academic.oup.com/evolut/advance-article-abstract/doi/10.1093/evolut/qpaf121/8155241?redirectedFrom=fulltext&login=false CREDITS Host der heutigen Folge ist Stefan Geier. Die Geschichten hat Hellmuth Nordwig recherchiert Wir freuen uns über Post von Euch: WhatsApp (https://wa.me/491746744240) oder iq@br.de Immer noch neugierig - und mehr Zeit? Dann empfehlen wir Euch unseren IQ Podcast, der in die Tiefe geht: IQ - Wissenschaft und Forschung Alle Folgen gibt es in der ARD Audiothek https://1.ard.de/IQWissenschaft

Stressen oder Chillen? - Das macht Stress mit Anführern | So geht Impfen mit Zahnseide
Wenig Zeit - trotzdem neugierig? Hier ist Euer Podcast Update für alles, was Ihr zu aktueller Forschung wissen müsst. Kurz, relevant und überraschend. Die Themen in dieser Podcast-Folge: (00:00:45) Anführer sind gestresst - Aber nicht nur die! https://www.sciencedirect.com/science/article/pii/S0960982225008255 (00:03:51) Impfen mit Zahnseide - Diese neue Idee funktioniert schon https://www.science.org/content/article/engineers-transform-dental-floss-needle-free-vaccine https://www.nature.com/articles/s41551-025-01451-3 CREDITS Host der heutigen Folge ist Stefan Geier. Die Geschichten hat Hellmuth Nordwig recherchiert Wir freuen uns über Post von Euch: WhatsApp (https://wa.me/491746744240) oder iq@br.de Immer noch neugierig - und mehr Zeit? Dann empfehlen wir Euch unseren IQ Podcast, der in die Tiefe geht: IQ - Wissenschaft und Forschung Alle Folgen gibt es in der ARD Audiothek https://1.ard.de/IQWissenschaft

Schulzeugnis - Sind Noten oder Worte verständlicher?
Zeugniszeit: Das Schuljahr ist jetzt auch für die letzten Schüler in Deutschland zu Ende. Aber wie muss das Zeugnis aussehen, damit alle, auch die Eltern verstehen, wie es ihren Kindern in der Schule eigentlich geht? Das hat eine Studie für Grundschüler untersucht. Daher unser Thema in dieser Podcast-Folge: Schulzeugnis - Sind Noten oder Worte verständlicher? CREDITS Host der heutigen Folge ist Stefan Geier. Die Geschichte hat Constanze Alvarez recherchiert Wir freuen uns über Post von Euch: WhatsApp (https://wa.me/491746744240) oder iq@br.de Immer noch neugierig - und mehr Zeit? Dann empfehlen wir Euch unseren IQ Podcast, der in die Tiefe geht: IQ - Wissenschaft und Forschung Alle Folgen gibt es in der ARD Audiothek https://1.ard.de/IQWissenschaft

Erdbebenwarnung am Smartphone - So gut funktioniert sie | Ältere Menschen sind oft mangelernährt - Das können wir tun
Wenig Zeit - trotzdem neugierig? Hier ist Euer Podcast Update für alles, was Ihr zu aktueller Forschung wissen müsst. Kurz, relevant und überraschend. Die Themen in dieser Podcast-Folge: (00:00:37) Erdbebenwarnung auf dem Smartphone https://www.eurekalert.org/news-releases/1090967 https://www.science.org/doi/10.1126/science.ads4779 (00:05:10) Mangelernährung bei älteren Menschen https://www.fau.de/2025/07/news/wissenschaft/mangelernaehrung-im-alter-ein-unterschaetztes-gesundheitsrisiko/ CREDITS Host der heutigen Folge ist Stefan Geier. Die Geschichten hat Hellmuth Nordwig recherchiert Wir freuen uns über Post von Euch: WhatsApp (https://wa.me/491746744240) oder iq@br.de Immer noch neugierig - und mehr Zeit? Dann empfehlen wir Euch unseren IQ Podcast, der in die Tiefe geht: IQ - Wissenschaft und Forschung Alle Folgen gibt es in der ARD Audiothek https://www.ardaudiothek.de/sendung/iq-wissenschaft-und-forschung/5941402/

Diese Babies haben drei Eltern | So reagieren wir unter Stress - Gegeneinander oder miteinander?
Wenig Zeit - trotzdem neugierig? Hier ist Euer Podcast Update für alles, was Ihr zu aktueller Forschung wissen müsst. Kurz, relevant und überraschend. Die Themen in dieser Podcast-Folge: (00:00:27) Unter Stress - Wann kooperieren wir? Und wann spielen wir gegeneinander? Dissociable glucocorticoid and noradrenergic effects on parochial cooperation and competition in intergroup conflict https://www.pnas.org/doi/10.1073/pnas.2502257122 (00:03:30) Diese Babies haben drei Eltern - Und keine Erbkrankheit mehr? Mitochondrial Donation and Preimplantation Genetic Testing for mtDNA Disease https://www.nejm.org/doi/full/10.1056/NEJMoa2415539 CREDITS Host der heutigen Folge ist Stefan Geier. Die Geschichten in dieser Podcast-Folge hat Oliver Buschek recherchiert Wir freuen uns über Post von Euch: WhatsApp (https://wa.me/491746744240) oder iq@br.de Immer noch neugierig - und mehr Zeit? Dann empfehlen wir Euch unseren IQ Podcast, der in die Tiefe geht: IQ - Wissenschaft und Forschung Alle Folgen gibt es in der ARD Audiothek https://www.ardaudiothek.de/sendung/iq-wissenschaft-und-forschung/5941402/

So weit verschieben Staudämme die Erdachse | Impfung gegen Pest - Erster Schritt mit mRNA
Wenig Zeit - trotzdem neugierig? Hier ist Euer Podcast Update für alles, was Ihr zu aktueller Forschung wissen müsst. Kurz, relevant und überraschend. Die Themen in dieser Podcast-Folge: (00:00:30) So weit verschieben Staudämme die Erdachse | https://agupubs.onlinelibrary.wiley.com/doi/10.1029/2025GL115468 (00:03:44) Impfung gegen Pest - Erster Schritt mit mRNA https://advanced.onlinelibrary.wiley.com/doi/10.1002/advs.202501286 Zum Weiterhören: Wo ist das Wasser? https://www.ardaudiothek.de/episode/urn:ard:episode:95bafeac64bca8ed/ Die Die Pest - Der schwarze Tod https://www.ardaudiothek.de/episode/urn:ard:publication:4c11926fee6414cd/ CREDITS Host der heutigen Folge ist Stefan Geier. Die Geschichten in dieser Podcast-Folge hat Oliver Buschek recherchiert Wir freuen uns über Post von Euch: WhatsApp (https://wa.me/491746744240) oder iq@br.de Immer noch neugierig - und mehr Zeit? Dann empfehlen wir Euch unseren IQ Podcast, der in die Tiefe geht: IQ - Wissenschaft und Forschung Alle Folgen gibt es in der ARD Audiothek https://www.ardaudiothek.de/sendung/iq-wissenschaft-und-forschung/5941402/

Tier-Spezial: Männer sind zwar oft stärker - haben aber nicht immer das Sagen | Auch Hummeln ernähren sich unvernünftig
Wenig Zeit - trotzdem neugierig? Hier ist Euer Podcast Update für alles, was Ihr zu aktueller Forschung wissen müsst. Kurz, relevant und überraschend. Die Themen in dieser Podcast-Folge: (00:00:35) Primaten-Männchen geben nicht immer den Ton an | The evolution of male-female dominance relations in primate societies https://www.pnas.org/doi/10.1073/pnas.2500405122 (00:02:45) Auch Hummeln ernähren sich unvernünftig - Wenn sie die Wahl haben Do bumble bees make optimal nutritional choices? https://www.sciencedirect.com/science/article/abs/pii/S0022191025000769? via%3Dihub https://www.eurekalert.org/news-releases/1089950 CREDITS Host der heutigen Folge ist Stefan Geier Die Geschichten in dieser Podcast-Folge hat Prisca Straub recherchiert Wir freuen uns über Post von Euch: WhatsApp (https://wa.me/491746744240) oder iq@br.de Immer noch neugierig - und mehr Zeit? Dann empfehlen wir Euch unseren IQ Podcast, der in die Tiefe geht: IQ - Wissenschaft und Forschung Alle Folgen gibt es in der ARD Audiothek https://www.ardaudiothek.de/sendung/iq-wissenschaft-und-forschung/5941402/

Neandertaler "Fettfabrik" gefunden | Der Wald beuhigt uns - Ein virtueller Wald auch!
Wenig Zeit - trotzdem neugierig? Hier ist Euer Podcast Update für alles, was Ihr zu aktueller Forschung wissen müsst. Kurz, relevant und überraschend. Die Themen in dieser Podcast-Folge: (00:00:43) Archäologischer Fund: die "Fettfabrik" der Neandertaler Large-scale processing of within-bone nutrients by Neanderthals, 125,000 years ago https://www.science.org/doi/10.1126/sciadv.adv1257 (00:03:03) Der Wald beruhigt und - Sogar, wenn er nur virtuell ist Virtuelles Waldbaden hilft beim Stressabbau https://www.mpg.de/25019169/0702-bild-virtuelles-waldbaden-hilft-beim-stressabbau-149835-x?c=2191 Zum Weiterhören: In dieser Folge von IQ-Wissenschaft und Forschung fragen wir nach der heilenden Wirkung des Waldes: Waldmedizin - So kann der Wald uns heilen https://www.ardaudiothek.de/episode/urn:ard:episode:3714ac38d86950f9/ CREDITS Host der heutigen Folge ist Stefan Geier Die Geschichten in dieser Podcast-Folge hat Prisca Straub recherchiert Immer noch neugierig - und mehr Zeit? Dann empfehlen wir Euch unseren IQ Podcast, der in die Tiefe geht: IQ - Wissenschaft und Forschung - alle Folgen gibt es in der ARD Audiothek https://www.ardaudiothek.de/sendung/iq-wissenschaft-und-forschung/5941402/

Trifft der Asteroid YR4 den Mond - Und damit die Erde? | Wann ist ein Mensch "cool"? | 2024 YR4
Wenig Zeit - trotzdem neugierig? Hier ist Euer Podcast Update für alles, was Ihr zu aktueller Forschung wissen müsst. Kurz, relevant und überraschend. Die Themen in dieser Podcast-Folge: (00:00:29) Der Asteroid YR4 sollte die Erde treffen - Jetzt vielleicht den Mond? - Und damit doch die Erde? Wie groß ist die Wahrscheinlichkeit? The Potential Danger to Satellites due to Ejecta from a 2032 Lunar Impact by Asteroid 2024 YR4 https://arxiv.org/abs/2506.11217 (00:02:55) Wann ist ein Mensch "cool"? Cool people. APA PsycNet https://psycnet.apa.org/doiLanding?doi=10.1037%2Fxge0001799 CREDITS Host der heutigen Folge ist Stefan Geier Die Geschichten in dieser Podcast-Folge hat Veronika Bräse recherchiert Immer noch neugierig - und mehr Zeit? Dann empfehlen wir Euch unseren IQ Podcast, der in die Tiefe geht: IQ - Wissenschaft und Forschung - alle Folgen gibt es in der ARD Audiothek https://www.ardaudiothek.de/sendung/iq-wissenschaft-und-forschung/5941402/

#239 Sport in der Hitze - Gefährlich oder besonders effektiv? - Worauf wir achten müssen
Wenig Zeit - trotzdem neugierig? Hier ist Euer Podcast Update für alles, was Ihr zu aktueller Forschung wissen müsst. Kurz, relevant und überraschend. Das Thema in dieser Podcast Folge: Sport in der Hitze - Besonders gesund oder besonders effektiv? CREDITS Host der heutigen Folge ist Stefan Geier Die Geschichte in dieser Podcast Folge hat Anna Küch recherchiert Redaktion: Miriam Stumpfe Die Originalstudie zu Sport in der Hitze findet Ihr hier Heat Training Efficiently Increases and Maintains Hemoglobin Mass and Temperate Endurance Performance in Elite Cyclists https://journals.lww.com/acsm-msse/fulltext/2022/09000/heat_training_efficiently_increases_and_maintains.13.aspx | Hier kann man gut sehen, was im Körper passiert, wenn wir bei Hitze trainieren und worauf wir achten sollten: Exercise under heat stress: thermoregulation, hydration, performance implications, and mitigation strategies https://journals.physiology.org/doi/full/10.1152/physrev.00038.2020?rfr_dat=cr_pub++0pubmed&url_ver=Z39.88-2003&rfr_id=ori%3Arid%3Acrossref.org Wir freuen uns, von Euch zu hören: WhatsApp (https://wa.me/491746744240) oder iq@br.de. Immer noch neugierig - und mehr Zeit? Dann empfehlen wir Euch unseren IQ Podcast, der in die Tiefe geht IQ - Wissenschaft und Forschung https://www.ardaudiothek.de/sendung/iq-wissenschaft-und-forschung/5941402/

#238 Ungewöhnliches beobachtet: Orcas nutzen Werkzeuge für Wellness und Gesundheit | Migranten sind immer besser ausgebildet
Wenig Zeit - trotzdem neugierig? Hier ist Euer Podcast Update für alles, was Ihr zu aktueller Forschung wissen müsst. Kurz, relevant und überraschend. Die Themen in dieser Podcast-Folge: (00:00:34) Zuwanderer - So gut sind Migranten ausgebildet | https://www.rfberlin.com/wp-content/uploads/2025/06/RFberlin_CReAM_Education-of-Migrants-in-the-European-Union_REP23062025.pdf (00:03:51) Ungewöhnliches Verhalten beobachtet: Orcas nutzen Werzkeuge - Für Wellness und Gesundheit Manufacture and use of allogrooming tools by wild killer whales https://www.cell.com/current-biology/fulltext/S0960-9822(25)00450-6 CREDITS Host der heutigen Folge ist Stefan Geier Die Geschichten in dieser Podcast-Folge hat Jenny von Sperber recherchiert Immer noch neugierig - und mehr Zeit? Dann empfehlen wir Euch unseren IQ Podcast, der in die Tiefe geht: IQ - Wissenschaft und Forschung https://www.ardaudiothek.de/sendung/iq-wissenschaft-und-forschung/5941402/ Alle Folgen von IQ gibt es auch in der https://www.ardaudiothek.de/.

#236 Scharf essen hilft beim Abnehmen | Kurzvideos sind schlecht für rationales Denken und Lernen | Neue Blutgruppe entdeckt?
Wenig Zeit - trotzdem neugierig? Hier ist Euer Podcast Update für alles, was Ihr zu aktueller Forschung wissen müsst. Kurz, relevant und überraschend. Die Themen in dieser Podcast-Folge: (00:00:55) Scharf essen hilft beim Abnehmen https://lnkd.in/ewvk9aQR | (00:03:02) Kurzvideos sind schlecht für rationales Denken https://www.sciencedirect.com/science/article/pii/S0360131525000983?via%3Dihub | (00:05:30) Neue Blutgruppe entdeckt? Wir freuen uns, von Euch zu hören: WhatsApp (https://wa.me/491746744240) oder iq@br.de. CREDITS Host der heutigen Folge ist Stefan Geier Die Geschichte in dieser Podcast-Folge haben Susi Weichselbaumer, Monika Haas und Jenny von Sperber recherchiert Immer noch neugierig - und mehr Zeit? Dann empfehlen wir Euch unseren IQ Podcast, der in die Tiefe geht: IQ - Wissenschaft und Forschung https://www.ardaudiothek.de/sendung/iq-wissenschaft-und-forschung/5941402/ Alle Folgen von IQ gibt es auch in der https://www.ardaudiothek.de/. In der aktuellen Folge geht es um unseren Schlaf und um Sleep Hacks - So kann man den Schlaf verbessern https://www.ardaudiothek.de/episode/urn:ard:episode:ad69f53a5e8de091/

#235 So einzigartig ist unser Atem - Wie ein Fingerabdruck | Riesensandale entdeckt
Wenig Zeit - trotzdem neugierig? Hier ist Euer Podcast Update für alles, was Ihr zu aktueller Forschung wissen müsst. Kurz, relevant und überraschend. Die Themen in dieser Podcast-Folge: (00:00:30) So einzigartig ist unser Atem - Wie ein Fingerabdruck https://www.cell.com/current-biology/fulltext/S0960-9822(25)00583-4 | (00:02:59) Riesensandale entdeckt - Fast 2000 Jahre alte römische Schuhsohle Mehr dazu findet Ihr im Ausgrabungs-Blog Roman Army Museum am Hadrianswall: https://romanarmymuseum.com/magnafort/magna-dig-diary-2025/ (Eintrag vom 21. Mai) Wir freuen uns, von Euch zu hören: WhatsApp (https://wa.me/491746744240) oder iq@br.de. CREDITS Host der heutigen Folge ist Miriam Stumpfe Die Geschichte in dieser Podcast-Folge hat Prisca Straub recherchiert Redaktion: Georgia Tscharke Immer noch neugierig - und mehr Zeit? Dann empfehlen wir Euch unseren IQ Podcast, der in die Tiefe geht: IQ - Wissenschaft und Forschung https://www.ardaudiothek.de/sendung/iq-wissenschaft-und-forschung/5941402/ Alle Folgen von IQ gibt es auch in der https://www.ardaudiothek.de/. Hier könnt ihr die letzten Folgen hören: Hautkrebs besser heilen? - Mit KI und neuen Therapien https://www.ardaudiothek.de/episode/urn:ard:publication:1d904609821b7cae/ Gift vor deutschen Küsten - Was tun mit alter Munition auf dem Meeresgrund? https://www.ardaudiothek.de/episode/urn:ard:publication:a344b4076aaf2c08/ Der automatisierte Krieg - Wenn autonome Waffen töten, ARD Audiothek https://www.ardaudiothek.de/episode/iq-wissenschaft-und-forschung/der-automatisierte-krieg-wenn-autonome-waffen-toeten/bayern-2/13960691/ Trügerisch echt - So fälscht unser Gehirn Erinnerungen https://www.ardaudiothek.de/episode/iq-wissenschaft-und-forschung/truegerisch-echt-so-faelscht-unser-gehirn-erinnerungen/bayern-2/14736297/ Prof. Algorithmus - So revolutioniert Künstliche Intelligenz die Forschung https://www.ardaudiothek.de/episode/iq-wissenschaft-und-forschung/prof-algorithmus-so-revolutioniert-kuenstliche-intelligenz-die-forschung/bayern-2/14728619/ Diesen Fehler haben wir im Gehirn eingebaut - So können wir ihn umgehen https://www.ardaudiothek.de/episode/iq-wissenschaft-und-forschung/diesen-fehler-haben-wir-im-gehirn-eingebaut-so-koennen-wir-ihn-umgehen/bayern-2/14610485/ Jugendliche depressiv durch Social Media? Neue Studie zeigt Zusammenhänge https://www.ardaudiothek.de/episode/iq-wissenschaft-und-forschung/jugendliche-depressiv-durch-social-media-neue-studie-zeigt-zusammenhaenge/bayern-2/14721871/ Künstliche Gebärmutter - Fortpflanzung ohne Sex und Schwangerschaft? https://www.ardaudiothek.de/episode/iq-wissenschaft-und-forschung/kuenstliche-gebaermutter-fortpflanzung-ohne-sex-und-schwangerschaft/bayern-2/14713677/ Ist das noch Essen? - Hochverarbeitete Lebensmittel - So wirken sie auf den Körper https://www.ardaudiothek.de/episode/iq-wissenschaft-und-forschung/ist-das-noch-essen-hochverarbeitete-lebensmittel-so-wirken-sie-auf-den-koerper/bayern-2/14706333/

#234 Vorfahre des T. Rex entdeckt: Der Drachenprinz der Mongolei | So schaut die Sonne von unten aus | Jungen und Mädchen sind gleich gut in Mathe - bis zum Schulstart
Wenig Zeit - trotzdem neugierig? Hier ist Euer Podcast Update für alles, was Ihr zu aktueller Forschung wissen müsst. Kurz, relevant und überraschend. Die Themen in dieser Podcast-Folge: (00:00:12) Vorfahre des T. Rex entdeckt: Der Drachenprinz der Mongolei | https://www.nature.com/articles/s41586-025-08964-6 (00:03:35) So schaut die Sonne von unten aus | https://www.esa.int/Science_Exploration/Space_Science/Solar_Orbiter/Solar_Orbiter_gets_world-first_views_of_the_Sun_s_poles (00:05:07) Geschlechterunterschiede in Mathematik erst nach dem Schulstart | https://www.nature.com/articles/s41586-025-09126-4 Wir freuen uns, von Euch zu hören: WhatsApp (https://wa.me/491746744240) oder iq@br.de. CREDITS Host der heutigen Folge ist Franzi Konitzer Die Geschichte in dieser Podcast-Folge hat Johannes Roßteuscher recherchiert Redaktion: Georgia Tscharke Immer noch neugierig - und mehr Zeit? Dann empfehlen wir Euch unseren IQ Podcast, der in die Tiefe geht: IQ - Wissenschaft und Forschung https://www.ardaudiothek.de/sendung/iq-wissenschaft-und-forschung/5941402/ Alle Folgen von IQ gibt es auch in der https://www.ardaudiothek.de/. Hier könnt ihr die letzten Folgen hören: Der automatisierte Krieg - Wenn autonome Waffen töten, ARD Audiothek https://www.ardaudiothek.de/episode/iq-wissenschaft-und-forschung/der-automatisierte-krieg-wenn-autonome-waffen-toeten/bayern-2/13960691/ Trügerisch echt - So fälscht unser Gehirn Erinnerungen https://www.ardaudiothek.de/episode/iq-wissenschaft-und-forschung/truegerisch-echt-so-faelscht-unser-gehirn-erinnerungen/bayern-2/14736297/ Prof. Algorithmus - So revolutioniert Künstliche Intelligenz die Forschung https://www.ardaudiothek.de/episode/iq-wissenschaft-und-forschung/prof-algorithmus-so-revolutioniert-kuenstliche-intelligenz-die-forschung/bayern-2/14728619/ Diesen Fehler haben wir im Gehirn eingebaut - So können wir ihn umgehen https://www.ardaudiothek.de/episode/iq-wissenschaft-und-forschung/diesen-fehler-haben-wir-im-gehirn-eingebaut-so-koennen-wir-ihn-umgehen/bayern-2/14610485/ Jugendliche depressiv durch Social Media? Neue Studie zeigt Zusammenhänge https://www.ardaudiothek.de/episode/iq-wissenschaft-und-forschung/jugendliche-depressiv-durch-social-media-neue-studie-zeigt-zusammenhaenge/bayern-2/14721871/ Künstliche Gebärmutter - Fortpflanzung ohne Sex und Schwangerschaft? https://www.ardaudiothek.de/episode/iq-wissenschaft-und-forschung/kuenstliche-gebaermutter-fortpflanzung-ohne-sex-und-schwangerschaft/bayern-2/14713677/ Ist das noch Essen? - Hochverarbeitete Lebensmittel - So wirken sie auf den Körper https://www.ardaudiothek.de/episode/iq-wissenschaft-und-forschung/ist-das-noch-essen-hochverarbeitete-lebensmittel-so-wirken-sie-auf-den-koerper/bayern-2/14706333/ Der Subpolarwirbel - Diesen Einfluss hat die rätselhafte Kälteblase | Klimawandel für Profis https://www.ardaudiothek.de/episode/iq-wissenschaft-und-forschung/der-subpolarwirbel-diesen-einfluss-hat-die-raetselhafte-kaelteblase-klimawandel-fuer-profis/bayern-2/14703197/ Achtung Zecken! - Neue Krankheitserreger drohen https://www.ardaudiothek.de/episode/iq-wissenschaft-und-forschung/achtung-zecken-neue-krankheitserreger-drohen-durch-blutsauger/bayern-2/14719087/ KI macht Musik - So komponiert künstliche Intelligenz - Besser als der Mensch? https://www.ardaudiothek.de/episode/iq-wissenschaft-und-forschung/ki-macht-musik-so-komponiert-kuenstliche-intelligenz-besser-als-der-mensch/bayern-2/14696431/ Essbare Batterien und Spiderman-Versuche - Warum "Jugend forscht" so wichtig ist https://www.ardaudiothek.de/episode/iq-wissenschaft-und-forschung/essbare-batterien-und-spiderman-versuche-warum-jugend-forscht-so-wichtig-ist/bayern-2/14674909/ Mitte Juni fällt die Nacht aus - Der Sternenhimmel https://www.ardaudiothek.de/episode/iq-wissenschaft-und-forschung/mitte-juni-faellt-die-nacht-aus-der-sternenhimmel/bayern-2/14653537/ Genetisch veränderte Lebewesen - So wichtig sind sie in der Medizin https://www.ardaudiothek.de/episode/iq-wissenschaft-und-forschung/genetisch-veraenderte-lebewesen-so-wichtig-sind-sie-in-der-medizin/bayern-2/14643089/ Fahrrad fahren - So wird es viel sicherer https://www.ardaudiothek.de/episode/iq-wissenschaft-und-forschung/fahrrad-fahren-so-wird-es-viel-sicherer/bayern-2/14635363/ Mythos oder Tatsache? Filterblasen im Internet https://www.ardaudiothek.de/episode/iq-wissenschaft-und-forschung/mythos-oder-tatsache-filterblasen-im-internet/bayern-2/14627251/ Wenn Chatbots manipulieren - So können wir uns schützen | Grok https://www.ardaudiothek.de/episode/iq-wissenschaft-und-forschung/wenn-chatbots-manipulieren-so-koennen-wir-uns-schuetzen-grok/bayern-2/14617231/ Wir freuen uns, von Euch zu hören. Schreibt uns gern unter iq@br.de oder schickt uns eine Sprachnachricht per WhatsApp (https://wa.me/491746744240)

#233 Unterwegs in der Stadt zu Fuß und mit dem Rad: Was bringt euch das? | Rekordhitze in Island und Grönland im Mai
Wenig Zeit - trotzdem neugierig? Hier ist Euer Podcast Update für alles, was Ihr zu aktueller Forschung wissen müsst. Kurz, relevant und überraschend. Die Themen in dieser Podcast-Folge: (00:00:24) Weltweit zweitwärmster Mai seit Beginn der Messungen | https://www.worldweatherattribution.org/climate-change-drives-record-breaking-heat-in-iceland-and-greenland-challenging-cold-adapted-ecosystems-and-societies/ (00:03:36) Unterwegs in der Stadt zu Fuß und mit dem Rad | https://www.pnas.org/doi/10.1073/pnas.2422334122 Wir freuen uns, von Euch zu hören: WhatsApp (https://wa.me/491746744240) oder iq@br.de. CREDITS Host der heutigen Folge ist Franzi Konitzer Die Geschichte in dieser Podcast-Folge hat Johannes Roßteuscher recherchiert Redaktion: Georgia Tscharke Immer noch neugierig - und mehr Zeit? Dann empfehlen wir Euch unseren IQ Podcast, der in die Tiefe geht: IQ - Wissenschaft und Forschung https://www.ardaudiothek.de/sendung/iq-wissenschaft-und-forschung/5941402/ Alle Folgen von IQ gibt es auch in der https://www.ardaudiothek.de/. Hier könnt ihr die letzten Folgen hören: Der automatisierte Krieg - Wenn autonome Waffen töten, ARD Audiothek https://www.ardaudiothek.de/episode/iq-wissenschaft-und-forschung/der-automatisierte-krieg-wenn-autonome-waffen-toeten/bayern-2/13960691/ Trügerisch echt - So fälscht unser Gehirn Erinnerungen https://www.ardaudiothek.de/episode/iq-wissenschaft-und-forschung/truegerisch-echt-so-faelscht-unser-gehirn-erinnerungen/bayern-2/14736297/ Prof. Algorithmus - So revolutioniert Künstliche Intelligenz die Forschung https://www.ardaudiothek.de/episode/iq-wissenschaft-und-forschung/prof-algorithmus-so-revolutioniert-kuenstliche-intelligenz-die-forschung/bayern-2/14728619/ Diesen Fehler haben wir im Gehirn eingebaut - So können wir ihn umgehen https://www.ardaudiothek.de/episode/iq-wissenschaft-und-forschung/diesen-fehler-haben-wir-im-gehirn-eingebaut-so-koennen-wir-ihn-umgehen/bayern-2/14610485/ Jugendliche depressiv durch Social Media? Neue Studie zeigt Zusammenhänge https://www.ardaudiothek.de/episode/iq-wissenschaft-und-forschung/jugendliche-depressiv-durch-social-media-neue-studie-zeigt-zusammenhaenge/bayern-2/14721871/ Künstliche Gebärmutter - Fortpflanzung ohne Sex und Schwangerschaft? https://www.ardaudiothek.de/episode/iq-wissenschaft-und-forschung/kuenstliche-gebaermutter-fortpflanzung-ohne-sex-und-schwangerschaft/bayern-2/14713677/ Ist das noch Essen? - Hochverarbeitete Lebensmittel - So wirken sie auf den Körper https://www.ardaudiothek.de/episode/iq-wissenschaft-und-forschung/ist-das-noch-essen-hochverarbeitete-lebensmittel-so-wirken-sie-auf-den-koerper/bayern-2/14706333/ Der Subpolarwirbel - Diesen Einfluss hat die rätselhafte Kälteblase | Klimawandel für Profis https://www.ardaudiothek.de/episode/iq-wissenschaft-und-forschung/der-subpolarwirbel-diesen-einfluss-hat-die-raetselhafte-kaelteblase-klimawandel-fuer-profis/bayern-2/14703197/ Achtung Zecken! - Neue Krankheitserreger drohen https://www.ardaudiothek.de/episode/iq-wissenschaft-und-forschung/achtung-zecken-neue-krankheitserreger-drohen-durch-blutsauger/bayern-2/14719087/ KI macht Musik - So komponiert künstliche Intelligenz - Besser als der Mensch? https://www.ardaudiothek.de/episode/iq-wissenschaft-und-forschung/ki-macht-musik-so-komponiert-kuenstliche-intelligenz-besser-als-der-mensch/bayern-2/14696431/ Essbare Batterien und Spiderman-Versuche - Warum "Jugend forscht" so wichtig ist https://www.ardaudiothek.de/episode/iq-wissenschaft-und-forschung/essbare-batterien-und-spiderman-versuche-warum-jugend-forscht-so-wichtig-ist/bayern-2/14674909/ Mitte Juni fällt die Nacht aus - Der Sternenhimmel https://www.ardaudiothek.de/episode/iq-wissenschaft-und-forschung/mitte-juni-faellt-die-nacht-aus-der-sternenhimmel/bayern-2/14653537/ Genetisch veränderte Lebewesen - So wichtig sind sie in der Medizin https://www.ardaudiothek.de/episode/iq-wissenschaft-und-forschung/genetisch-veraenderte-lebewesen-so-wichtig-sind-sie-in-der-medizin/bayern-2/14643089/ Fahrrad fahren - So wird es viel sicherer https://www.ardaudiothek.de/episode/iq-wissenschaft-und-forschung/fahrrad-fahren-so-wird-es-viel-sicherer/bayern-2/14635363/ Mythos oder Tatsache? Filterblasen im Internet https://www.ardaudiothek.de/episode/iq-wissenschaft-und-forschung/mythos-oder-tatsache-filterblasen-im-internet/bayern-2/14627251/ Wenn Chatbots manipulieren - So können wir uns schützen | Grok https://www.ardaudiothek.de/episode/iq-wissenschaft-und-forschung/wenn-chatbots-manipulieren-so-koennen-wir-uns-schuetzen-grok/bayern-2/14617231/ Wir freuen uns, von Euch zu hören. Schreibt uns gern unter iq@br.de oder schickt uns eine Sprachnachricht per WhatsApp (https://wa.me/491746744240)

#232 Super-Erde in weit entferntem Sonnensystem entdeckt | Was macht den Exoplanet Kepler 725-c so besonders?
Wenig Zeit - trotzdem neugierig? Hier ist Euer Podcast Update für alles, was Ihr zu aktueller Forschung wissen müsst. Kurz, relevant und überraschend. Das Thema in dieser Podcast-Folge: (00:00:20) Exoplanet Kepler 725-c in weit entferntem Sonnensystem entdeckt. Der Exoplanet Kepler 725-c in der habitablen Zone um seine Sonne. Hier ist die Originalquelle dieser Podcast-Folge: https://www.nature.com/articles/s41550-025-02565-z | Wir freuen uns, von Euch zu hören: WhatsApp (https://wa.me/491746744240) oder iq@br.de. CREDITS Host der heutigen Folge ist Franzi Konitzer Die Geschichte in dieser Podcast-Folge hat Johannes Roßteuscher recherchiert Redaktion: Georgia Tscharke Wenn ihr noch mehr über Exoplaneten und die Suche nach der zweiten Erde herausfinden möchtet: Exoplaneten - Wann finden wir die zweite Erde? https://www.ardaudiothek.de/episode/iq-wissenschaft-und-forschung/exoplaneten-wann-finden-wir-die-zweite-erde/bayern-2/14593575/ Immer noch neugierig - und mehr Zeit? Dann empfehlen wir Euch unseren IQ Podcast, der in die Tiefe geht: IQ - Wissenschaft und Forschung https://www.ardaudiothek.de/sendung/iq-wissenschaft-und-forschung/5941402/ Alle Folgen von IQ gibt es auch in der https://www.ardaudiothek.de/. Hier könnt ihr die letzten Folgen hören: Der automatisierte Krieg - Wenn autonome Waffen töten, ARD Audiothek https://www.ardaudiothek.de/episode/iq-wissenschaft-und-forschung/der-automatisierte-krieg-wenn-autonome-waffen-toeten/bayern-2/13960691/ Trügerisch echt - So fälscht unser Gehirn Erinnerungen https://www.ardaudiothek.de/episode/iq-wissenschaft-und-forschung/truegerisch-echt-so-faelscht-unser-gehirn-erinnerungen/bayern-2/14736297/ Prof. Algorithmus - So revolutioniert Künstliche Intelligenz die Forschung https://www.ardaudiothek.de/episode/iq-wissenschaft-und-forschung/prof-algorithmus-so-revolutioniert-kuenstliche-intelligenz-die-forschung/bayern-2/14728619/ Diesen Fehler haben wir im Gehirn eingebaut - So können wir ihn umgehen https://www.ardaudiothek.de/episode/iq-wissenschaft-und-forschung/diesen-fehler-haben-wir-im-gehirn-eingebaut-so-koennen-wir-ihn-umgehen/bayern-2/14610485/ Jugendliche depressiv durch Social Media? Neue Studie zeigt Zusammenhänge https://www.ardaudiothek.de/episode/iq-wissenschaft-und-forschung/jugendliche-depressiv-durch-social-media-neue-studie-zeigt-zusammenhaenge/bayern-2/14721871/ Künstliche Gebärmutter - Fortpflanzung ohne Sex und Schwangerschaft? https://www.ardaudiothek.de/episode/iq-wissenschaft-und-forschung/kuenstliche-gebaermutter-fortpflanzung-ohne-sex-und-schwangerschaft/bayern-2/14713677/ Ist das noch Essen? - Hochverarbeitete Lebensmittel - So wirken sie auf den Körper https://www.ardaudiothek.de/episode/iq-wissenschaft-und-forschung/ist-das-noch-essen-hochverarbeitete-lebensmittel-so-wirken-sie-auf-den-koerper/bayern-2/14706333/ Der Subpolarwirbel - Diesen Einfluss hat die rätselhafte Kälteblase | Klimawandel für Profis https://www.ardaudiothek.de/episode/iq-wissenschaft-und-forschung/der-subpolarwirbel-diesen-einfluss-hat-die-raetselhafte-kaelteblase-klimawandel-fuer-profis/bayern-2/14703197/ Achtung Zecken! - Neue Krankheitserreger drohen https://www.ardaudiothek.de/episode/iq-wissenschaft-und-forschung/achtung-zecken-neue-krankheitserreger-drohen-durch-blutsauger/bayern-2/14719087/ KI macht Musik - So komponiert künstliche Intelligenz - Besser als der Mensch? https://www.ardaudiothek.de/episode/iq-wissenschaft-und-forschung/ki-macht-musik-so-komponiert-kuenstliche-intelligenz-besser-als-der-mensch/bayern-2/14696431/ Essbare Batterien und Spiderman-Versuche - Warum "Jugend forscht" so wichtig ist https://www.ardaudiothek.de/episode/iq-wissenschaft-und-forschung/essbare-batterien-und-spiderman-versuche-warum-jugend-forscht-so-wichtig-ist/bayern-2/14674909/ Mitte Juni fällt die Nacht aus - Der Sternenhimmel https://www.ardaudiothek.de/episode/iq-wissenschaft-und-forschung/mitte-juni-faellt-die-nacht-aus-der-sternenhimmel/bayern-2/14653537/ Genetisch veränderte Lebewesen - So wichtig sind sie in der Medizin https://www.ardaudiothek.de/episode/iq-wissenschaft-und-forschung/genetisch-veraenderte-lebewesen-so-wichtig-sind-sie-in-der-medizin/bayern-2/14643089/ Fahrrad fahren - So wird es viel sicherer https://www.ardaudiothek.de/episode/iq-wissenschaft-und-forschung/fahrrad-fahren-so-wird-es-viel-sicherer/bayern-2/14635363/ Mythos oder Tatsache? Filterblasen im Internet https://www.ardaudiothek.de/episode/iq-wissenschaft-und-forschung/mythos-oder-tatsache-filterblasen-im-internet/bayern-2/14627251/ Wenn Chatbots manipulieren - So können wir uns schützen | Grok https://www.ardaudiothek.de/episode/iq-wissenschaft-und-forschung/wenn-chatbots-manipulieren-so-koennen-wir-uns-schuetzen-grok/bayern-2/14617231/ Wir freuen uns, von Euch zu hören. Schreibt uns gern unter iq@br.de oder schickt uns eine Sprachnachricht per WhatsApp (https://wa.me/491746744240)

#231 Seltenes Himmelsphänomen in Süddeutschland - Kanadas Aschewolke bald überall zu sehen?
Es war kein Saharastaub. Aber der Himmel über Süddeutschland war kurz nach Pfingsten 2025 in ein sonderbares Licht getaucht. Was ist das? Haben sich viele gefragt. Wie es zu diesem komischen Himmelsphänomen gekommen ist und ob wir es in Zukunft öfter über Deutschland sehen werden, das klären wir in dieser Podcast-Folge. Quellen: Deutscher Wetterdienst: https://www.dwd.de/DE/Home/home_node.html Copernicus Hier könnt Ihr die Aerosol-Verteilung über die ganze Welt auf den Seiten des Copernicus-Programms, Erdbeobachtung genau verfolgen: https://tinyurl.com/AerosolverteilungCopernicus Wir freuen uns, von Euch zu hören: WhatsApp (https://wa.me/491746744240) oder iq@br.de. CREDITS Host der heutigen Folge ist Stefan Geier Die Geschichte in dieser Podcast-Folge hat Johannes Roßteuscher recherchiert Redaktion: Georgia Tscharke Zum Weiterhören: Immer noch neugierig - und mehr Zeit? Dann empfehlen wir Euch unseren IQ Podcast, der in die Tiefe geht: IQ - Wissenschaft und Forschung https://www.ardaudiothek.de/sendung/iq-wissenschaft-und-forschung/5941402/ Hier könnt ihr die letzten Folgen hören: Der automatisierte Krieg - Wenn autonome Waffen töten, https://www.ardaudiothek.de/episode/iq-wissenschaft-und-forschung/der-automatisierte-krieg-wenn-autonome-waffen-toeten/bayern-2/13960691/ Trügerisch echt - So fälscht unser Gehirn Erinnerungen https://www.ardaudiothek.de/episode/iq-wissenschaft-und-forschung/truegerisch-echt-so-faelscht-unser-gehirn-erinnerungen/bayern-2/14736297/ Prof. Algorithmus - So revolutioniert Künstliche Intelligenz die Forschung https://www.ardaudiothek.de/episode/iq-wissenschaft-und-forschung/prof-algorithmus-so-revolutioniert-kuenstliche-intelligenz-die-forschung/bayern-2/14728619/ Diesen Fehler haben wir im Gehirn eingebaut - So können wir ihn umgehen https://www.ardaudiothek.de/episode/iq-wissenschaft-und-forschung/diesen-fehler-haben-wir-im-gehirn-eingebaut-so-koennen-wir-ihn-umgehen/bayern-2/14610485/ Jugendliche depressiv durch Social Media? Neue Studie zeigt Zusammenhänge https://www.ardaudiothek.de/episode/iq-wissenschaft-und-forschung/jugendliche-depressiv-durch-social-media-neue-studie-zeigt-zusammenhaenge/bayern-2/14721871/ Künstliche Gebärmutter - Fortpflanzung ohne Sex und Schwangerschaft? https://www.ardaudiothek.de/episode/iq-wissenschaft-und-forschung/kuenstliche-gebaermutter-fortpflanzung-ohne-sex-und-schwangerschaft/bayern-2/14713677/ Ist das noch Essen? - Hochverarbeitete Lebensmittel - So wirken sie auf den Körper https://www.ardaudiothek.de/episode/iq-wissenschaft-und-forschung/ist-das-noch-essen-hochverarbeitete-lebensmittel-so-wirken-sie-auf-den-koerper/bayern-2/14706333/ Der Subpolarwirbel - Diesen Einfluss hat die rätselhafte Kälteblase | Klimawandel für Profis https://www.ardaudiothek.de/episode/iq-wissenschaft-und-forschung/der-subpolarwirbel-diesen-einfluss-hat-die-raetselhafte-kaelteblase-klimawandel-fuer-profis/bayern-2/14703197/ Achtung Zecken! - Neue Krankheitserreger drohen https://www.ardaudiothek.de/episode/iq-wissenschaft-und-forschung/achtung-zecken-neue-krankheitserreger-drohen-durch-blutsauger/bayern-2/14719087/ KI macht Musik - So komponiert künstliche Intelligenz - Besser als der Mensch? https://www.ardaudiothek.de/episode/iq-wissenschaft-und-forschung/ki-macht-musik-so-komponiert-kuenstliche-intelligenz-besser-als-der-mensch/bayern-2/14696431/ Essbare Batterien und Spiderman-Versuche - Warum "Jugend forscht" so wichtig ist https://www.ardaudiothek.de/episode/iq-wissenschaft-und-forschung/essbare-batterien-und-spiderman-versuche-warum-jugend-forscht-so-wichtig-ist/bayern-2/14674909/ Mitte Juni fällt die Nacht aus - Der Sternenhimmel https://www.ardaudiothek.de/episode/iq-wissenschaft-und-forschung/mitte-juni-faellt-die-nacht-aus-der-sternenhimmel/bayern-2/14653537/ Genetisch veränderte Lebewesen - So wichtig sind sie in der Medizin https://www.ardaudiothek.de/episode/iq-wissenschaft-und-forschung/genetisch-veraenderte-lebewesen-so-wichtig-sind-sie-in-der-medizin/bayern-2/14643089/ Fahrrad fahren - So wird es viel sicherer https://www.ardaudiothek.de/episode/iq-wissenschaft-und-forschung/fahrrad-fahren-so-wird-es-viel-sicherer/bayern-2/14635363/ Mythos oder Tatsache? Filterblasen im Internet https://www.ardaudiothek.de/episode/iq-wissenschaft-und-forschung/mythos-oder-tatsache-filterblasen-im-internet/bayern-2/14627251/ Wenn Chatbots manipulieren - So können wir uns schützen | Grok https://www.ardaudiothek.de/episode/iq-wissenschaft-und-forschung/wenn-chatbots-manipulieren-so-koennen-wir-uns-schuetzen-grok/bayern-2/14617231/ Wir freuen uns, von Euch zu hören. Schreibt uns gern unter iq@br.de oder schickt uns eine Sprachnachricht per WhatsApp (https://wa.me/491746744240)

#230 So alt sind die Qumranrollen | Finger verschrumpeln immer nach dem gleichen Muster
Wenig Zeit - trotzdem neugierig? Hier ist Euer Podcast Update für alles, was Ihr zu aktueller Forschung wissen müsst. Kurz, relevant und überraschend. Die Themen in dieser Podcast-Folge: (00:00:17) So alt sind die Qumranrollen (00:03:59) Finger verschrumpeln im Wasser immer gleich Wir freuen uns, von Euch zu hören: WhatsApp (https://wa.me/491746744240) oder iq@br.de

#229 Später Kaffee hemmt das Lernen | Riesenflohkrebse bevölkern die Tiefsee
Wenig Zeit - trotzdem neugierig? Hier ist Euer Podcast Update für alles, was Ihr zu aktueller Forschung wissen müsst. Kurz, relevant und überraschend. Die Themen in dieser Podcast-Folge: (00:00:18) Riesenflohkrebse bevölkern die Tiefsee (00:03:11) Später Kaffee hemmt offenbar das Lernen Wir freuen uns, von Euch zu hören: WhatsApp (https://wa.me/491746744240) oder iq@br.de

#228 Wenn Wissen gehortet wird - der Gollum-Effekt in der Wissenschaft
Wenig Zeit - trotzdem neugierig? Hier ist Euer Podcast Update für alles, was Ihr zu aktueller Forschung wissen müsst. Kurz, relevant und überraschend. Das Thema in dieser Podcast-Folge: Der Gollum-Effekt - wenn Forscher ihr Wissen horten.https://www.sciencedirect.com/science/article/pii/S259033222500140XWir freuen uns, von Euch zu hören: WhatsApp (https://wa.me/491746744240) oder iq@br.de

#227 Deshalb sollten wir Babys öfter vorsingen | Menstruation - Dieser Bluttest könnte einfach auf Krankheiten hinweisen
Wenig Zeit - trotzdem neugierig? Hier ist Euer Podcast Update für alles, was Ihr zu aktueller Forschung wissen müsst. Kurz, relevant und überraschend. Die Themen in dieser Podcast-Folge: (00:00:28) Deshalb sollten wir Babys öfter vorsingen | https://srcd.onlinelibrary.wiley.com/doi/10.1111/cdev.14246 (00:03:42) Menstruation - Dieser Bluttest könnte einfach auf Krankheiten hinweisen https://advanced.onlinelibrary.wiley.com/doi/10.1002/advs.202505170?af=R Wir freuen uns, von Euch zu hören: WhatsApp (https://wa.me/491746744240) oder iq@br.de

#226 Noch schneller abhängig - Mit Einweg E-Zigaretten Vapes | Dieser Habicht hat eine geniale Jagd-Technik erfunden
Ab 1. Juni sind in Großbritannien Einweg-E-Zigaretten verboten. In dieser Podcast-Folge am Weltnichtrauchertag 2025 erzählen wir unter anderem (00:00:40) Warum Einweg-E-Zigaretten so gefährlich sind. https://www.nature.com/articles/s41598-025-97491-5 (00:03:46) Dieser Habicht hat eine erstaunlich geniale Jagdmethode entwickelt https://www.frontiersin.org/journals/ethology/articles/10.3389/fetho.2025.1539103/full Wir freuen uns, von Euch zu hören: WhatsApp (https://wa.me/491746744240) oder iq@br.de

#225 Deshalb sind Männer größer als Frauen | So verhandelt Künstliche Intelligenz KI
Wenig Zeit - trotzdem neugierig? Hier ist Euer Podcast Update für alles, was Ihr zu aktueller Forschung wissen müsst. Kurz, relevant und überraschend. Die Themen in dieser Podcast-Folge: (00:00:23) Wie KI verhandelt (00:03:25) Wie das Y-Chromosom die Körpergröße beeinflusst. Wir freuen uns, von Euch zu hören: WhatsApp (https://wa.me/491746744240) oder iq@br.de

#224 So verändern Töne unsere Zellen
Wenig Zeit - trotzdem neugierig? Hier ist Euer Podcast Update für alles, was Ihr zu aktueller Forschung wissen müsst. Kurz, relevant und überraschend. Das Thema in dieser Podcast-Folge: Töne und Geräusche verändern Zellen Wir freuen uns, von Euch zu hören: WhatsApp (https://wa.me/491746744240) oder iq@br.de

#223 E-Scooter-Fahren könnte sicherer werden | Regenwald verschwindet im Rekordtempo
Wenig Zeit - trotzdem neugierig? Hier ist Euer Podcast Update für alles, was Ihr zu aktueller Forschung wissen müsst. Kurz, relevant und überraschend. Die Themen in dieser Podcast-Folge: (00:00:23) Der Regenwald verschwindet immer schneller. (00:02:58) E-Scooter-Fahren könnte sicherer werden. Wir freuen uns, von Euch zu hören: WhatsApp (https://wa.me/491746744240) oder iq@br.de.

#222 Invasive Art: Der Waschbär ist ein Problem-Bär | Ist das Leben erleuchtet?
Wenig Zeit - trotzdem neugierig? Hier ist Euer Podcast Update für alles, was Ihr zu aktueller Forschung wissen müsst. Kurz, relevant und überraschend. Die Themen in dieser Podcast-Folge: (00:00:22) Der Waschbär als Problem-Bär (00:03:28) Die Erleuchtung des Lebens. Wir freuen uns, von Euch zu hören: WhatsApp(https://wa.me/491746744240) oder iq@br.de.

#221 Künstliche Süßstoffe machen Euer Gehirn hungrig | Trommelnde Schimpansen - so musikalisch sind sie
Wenig Zeit - trotzdem neugierig? Hier ist Euer Podcast Update für alles, was Ihr zu aktueller Forschung wissen müsst. Kurz, relevant und überraschend. Die Themen in dieser Podcast-Folge: (00:00:32) Künstliche Süßstoffe machen hungrig https://doi.org/10.1038/s42255-025-01227-8 | (00:04:15) So musikalisch sind Schimpansen - sie trommeln https://www.cell.com/current-biology/fulltext/S0960-9822(25)00448-8 Wir freuen uns, von Euch zu hören: WhatsApp (https://wa.me/491746744240) oder iq@br.de. Und hier geht's zur ersten Folge von "WirTier"! https://1.ard.de/wir-tier

#220 Gesichter erkennen per DNA? Die KI kann das!
Wenig Zeit - trotzdem neugierig? Hier ist Euer Podcast Update für alles, was Ihr zu aktueller Forschung wissen müsst. Kurz, relevant und überraschend. Das Thema in dieser Podcast-Folge: (00:00:23) Gesichter erkennen per DNA - Mit künstlicher Intelligenz https://advanced.onlinelibrary.wiley.com/doi/10.1002/advs.202414507 Wir freuen uns, von Euch zu hören: WhatsApp (https://wa.me/491746744240) oder iq@br.de.

#218 Richtig Wäschewaschen - Wann sterben die Bakterien? | Tintenfisch-Sprache entschlüsselt - Sie winken sich zu
Wenig Zeit - trotzdem neugierig? Hier ist Euer Podcast Update für alles, was Ihr zu aktueller Forschung wissen müsst. Kurz, relevant und überraschend. Die Themen in dieser Podcast-Folge: (00:00:28) Richtig Wäschewaschen - Wann sterben die Bakterien? https://journals.plos.org/plosone/article?id=10.1371/journal.pone.0321467 (00:03:55) Sprache der Tintenfische entschlüsselt - Sie winken sich zu https://www.biorxiv.org/content/10.1101/2025.04.13.648584v3 || Wir freuen uns, von Euch zu hören: WhatsApp (https://wa.me/491746744240) oder iq@br.de

#217 Fußball-Fans lösen Erdbeben aus - Richterskala | Warum grade Eichhörnchen von den Bäumen fallen
Wenig Zeit - trotzdem neugierig? Hier ist Euer Podcast Update für alles, was Ihr zu aktueller Forschung wissen müsst. Kurz, relevant und überraschend. Die Themen in dieser Podcast-Folge: (00:00:28) Fußball Fans von Liverpool jubeln bis zum Erdbeben University scientists show Liverpool's Premier League title win was a seismic event https://www.liverpool.ac.uk/earth-ocean-and-ecological-sciences/news/articles/university-scientists-show-liverpools-premier-league-title-win-was-a-seismic-event/ || (00:03:55) Warum Eichhörnchen vermehrt von Bäumen fallen Wenn Eichhörnchen vom Baum fallen https://www.sueddeutsche.de/panorama/eichhoernchen-baum-absturz-klimawandel-trockenheit-li.3243260 Deutschlandweit war es von Anfang Februar bis Mitte April noch nie seit 1931 so trocken (Deutscher Wetterdienst) https://www.dwd.de/DE/presse/pressemitteilungen/DE/2025/20250415_pm_trockenheit.pdf?__blob=publicationFile&v=2 Host der heutigen Folge ist Stefan Geier Die Geschichten in dieser Podcast Folge hat Prisca Straub recherchiert Redaktion: Georgia Tscharke Wir freuen uns, von Euch zu hören: WhatsApp (https://wa.me/491746744240) oder iq@br.de Immer noch neugierig - und mehr Zeit? Dann empfehlen wir Euch unseren IQ Podcast, der in die Tiefe geht IQ - Wissenschaft und Forschung https://www.ardaudiothek.de/sendung/iq-wissenschaft-und-forschung/5941402/ Hier könnt ihr die letzten Folgen hören: Immer noch neugierig - und mehr Zeit? Dann empfehlen wir Euch unseren IQ Podcast, der in die Tiefe geht IQ - Wissenschaft und Forschung Hier könnt ihr die letzten Folgen hören: Das geheime Wissen der Tiere https://www.ardaudiothek.de/episode/iq-wissenschaft-und-forschung/das-geheime-wissen-der-tiere-so-koennen-wir-es-mit-hightech-nutzen/bayern-2/14535183/ Mega-Röhren unter den Alpen - So entsteht der Brenner Basistunnel https://www.ardaudiothek.de/episode/iq-wissenschaft-und-forschung/mega-roehren-unter-den-alpen-so-entsteht-der-brenner-basistunnel/bayern-2/14529361/ Mind-Reading - Können Maschinen Gedanken lesen? https://www.ardaudiothek.de/episode/iq-wissenschaft-und-forschung/mind-reading-koennen-maschinen-gedanken-lesen/bayern-2/14523859/ Arche Noah entdeckt!? - Warum der Sintflut-Mythos wirklich spannend ist https://www.ardaudiothek.de/episode/iq-wissenschaft-und-forschung/arche-noah-entdeckt-warum-der-sintflut-mythos-wirklich-spannend-ist/bayern-2/14513073/ Der neue Kampf gegen Schmerzen - Mit KI, Opioiden und Biomarkern https://www.ardaudiothek.de/episode/iq-wissenschaft-und-forschung/der-neue-kampf-gegen-schmerzen-mit-ki-opioiden-und-biomarkern/bayern-2/14504513/ Archäologie des Feuers - Der lange Weg vom Buschbrand zum Ofen https://www.ardaudiothek.de/episode/iq-wissenschaft-und-forschung/archaeologie-des-feuers-der-lange-weg-vom-buschbrand-zum-ofen/bayern-2/14491375/ Grönlands Rohstoffe - Unerreichbarer Schatz unter Eis? https://www.ardaudiothek.de/episode/iq-wissenschaft-und-forschung/groenlands-rohstoffe-unerreichbarer-schatz-unter-eis/bayern-2/14480827/ Das Ende der Tierversuche? - So viel können künstliche Mini-Organe https://www.ardaudiothek.de/episode/iq-wissenschaft-und-forschung/das-ende-der-tierversuche-so-viel-koennen-kuenstliche-mini-organe/bayern-2/14483369/

#216 Elefanten im deutschen Wald | Wer ist stärker - Eiszeit oder Mensch?
Wenig Zeit - trotzdem neugierig? Hier ist Euer Podcast Update für alles, was Ihr zu aktueller Forschung wissen müsst. Kurz, relevant und überraschend. Die Themen in dieser Podcast-Folge: (00:00:27) Elefanten im deutschen Wald - waren früher normal https://biogeography.pensoft.net/article/135081/ | (00:03:05) Eiszeit oder Mensch - wer ist stärker? https://shorturl.at/ScrIG Wir freuen uns, von Euch zu hören: WhatsApp (https://wa.me/491746744240) oder iq@br.de

#215 Hungrig einkaufen? - Deswegen sollten wir es nicht tun | Bienen stechen unterschiedlich gern - je nach Charakter
Wenig Zeit - trotzdem neugierig? Hier ist Euer Podcast Update für alles, was Ihr zu aktueller Forschung wissen müsst. Kurz, relevant und überraschend. Die Themen in dieser Podcast-Folge: (00:00:27) Hungrig einkaufen? Warum das keine gute Idee ist https://elifesciences.org/reviewed-preprints/103736 (00:03:05) Bienen stechen unterschiedliche gerne - je nach Charakter? https://royalsocietypublishing.org/doi/full/10.1098/rsos.241295 Wir freuen uns, von Euch zu hören: WhatsApp (https://wa.me/491746744240) oder iq@br.de

#214 So viel Wald gibt es auf der Welt - Biomass-Satellit soll das Lungenvolumen der Erde entschlüsseln
Wenig Zeit - trotzdem neugierig? Hier ist Euer Podcast Update für alles, was Ihr zu aktueller Forschung wissen müsst. Kurz, relevant und überraschend. Das Thema dieser Podcast-Folge: Biomass-Satellitenmission soll die Wälder der Erde erforschen, man könnte auch sagen: er soll das Lungenvolumen unseres Planeten entschlüsseln. Wie kann uns das gegen den Klimawandel helfen und welche Hürden muss der Satellit noch überwinden, obwohl er schon im All ist? https://www.esa.int/Applications/Observing_the_Earth/FutureEO/Biomass Wir freuen uns, von Euch zu hören: WhatsApp (https://wa.me/491746744240) oder iq@br.de

#213 Kinderspielzeug - So will die EU Chemikalien besser kontrollieren
Wenig Zeit - trotzdem neugierig? Hier ist Euer Podcast Update für alles, was Ihr zu aktueller Forschung wissen müsst. Kurz, relevant und überraschend. Das Thema dieser Podcast-Folge: (00:00:18) EU will Chemikalien in Kinderspielzeug besser kontrollieren. Wir freuen uns, von Euch zu hören: WhatsApp (https://wa.me/491746744240) oder iq@br.de

#212 Bonobo-Schimpansen mögen Gerechtigkeit | Fadenwürmer inspirieren Roboter
Wenig Zeit - trotzdem neugierig? Hier ist Euer Podcast Update für alles, was Ihr zu aktueller Forschung wissen müsst. Kurz, relevant und überraschend. Die Themen in dieser Podcast-Folge: (00:00:12) Bonobos haben offenbar Sinn für Gerechtigkeit (00:03:29) Fadenwürmer inspirieren Roboter. Wir freuen uns, von Euch zu hören: WhatsApp (https://wa.me/491746744240) oder iq@br.de

#211 Früherkennung der Schizophrenie | Antiker Pferdefriedhof
Wenig Zeit - trotzdem neugierig? Hier ist Euer Podcast Update für alles, was Ihr zu aktueller Forschung wissen müsst. Kurz, relevant und überraschend. Die Themen in dieser Podcast-Folge: (00:00:25) Früherkennung der Schizophrenie per Augendiagnostik (00:03:37) Antiker Pferdefriedhof bei Stuttgart entdeckt. Wir freuen uns, von Euch zu hören: WhatsApp (https://wa.me/491746744240) oder iq@br.de

#2010 Tier-Spezial: Krähen verstehen Geometrie - Und das ist angeboren | Psychopharmaka im Abwasser macht Lachse mutiger
Wenig Zeit - trotzdem neugierig? Hier ist Euer Podcast Update für alles, was Ihr zu aktueller Forschung wissen müsst. Kurz, relevant und überraschend. Die Themen in dieser Podcast-Folge: (00:00:28) "Gedopte" Lachse werden mutiger https://www.science.org/doi/10.1126/science.adp7174 (00:02:11) Krähen können geometrische Formen erkennen https://www.science.org/doi/10.1126/sciadv.adt3718 | Wir freuen uns, von Euch zu hören: WhatsApp (https://wa.me/491746744240) oder iq@br.de.

#209 Schlechte Umweltbilanz von Hunden - So kann man sie deutlich verbessern | Denisovaner - Spektakulärer Fund des Frühmenschen in einem Museum
Wenig Zeit - trotzdem neugierig? Hier ist Euer Podcast Update für alles, was Ihr zu aktueller Forschung wissen müsst. Kurz, relevant und überraschend. Die Themen in dieser Podcast-Folge: (00:00:30) Die Umweltbilanz von Hunden - So kann man sie deutlich verbessern https://www.publish.csiro.au/PC/PC24071 (00:02:38) Denisovaner - Wo lebten die Neandertaler Asiens? Ein spektakulärer Fund in einem Museum zeigt neue Verbreitung der Frühmenschen https://www.science.org/doi/10.1126/science.ads3888 | Wir freuen uns, von Euch zu hören: WhatsApp (https://wa.me/491746744240) oder iq@br.de.

#207 Konzentration beim Lernen - Dann sollten wir die Gedanken schweifen lassen | Vögel sind bunter in der Stadt - Warum?
Wenig Zeit - trotzdem neugierig? Hier ist Euer Podcast Update für alles, was Ihr zu aktueller Forschung wissen müsst. Kurz, relevant und überraschend. Die Themen in dieser Podcast-Folge: (00:00:28) Nebenbei lernen ohne Fokus kann in manchen Fällen helfen https://dx.doi.org/10.1523/JNEUROSCI.1421-24.2025 (00:02:40) Warum sind Vögel bunter in der Stadt? https://onlinelibrary.wiley.com/doi/10.1111/ele.70106 | Wir freuen uns, von Euch zu hören: WhatsApp (https://wa.me/491746744240) oder iq@br.de.

#206 Kaffee wird teurer - So brüht man perfekt trotz wenig Kaffee | Blutspenden - Deswegen ist es gut für den eigenen Körper
Wenig Zeit - trotzdem neugierig? Hier ist Euer Podcast Update für alles, was Ihr zu aktueller Forschung wissen müsst. Kurz, relevant und überraschend. Die Themen in dieser Podcast-Folge: (00:00:22) Blut spenden ist gut für den eigenen Körper - Und rettet Leben https://www.aerzteblatt.de/news/haufige-blutspenden-konnten-das-knochenmark-starken-e54ea28d-5039-45c5-af7c-682c0ddcb784 (00:02:53) So gelingt der perfekte Kaffee mit wenig Pulver https://pubs.aip.org/aip/pof/article-abstract/37/4/043332/3342795/Pour-over-coffee-Mixing-by-a-water-jet-impinging | Wir freuen uns, von Euch zu hören: WhatsApp (https://wa.me/491746744240) oder iq@br.de.

#204 Jodelnde Affen | Weltrekord für durchsichtige Solarzellen
Wenig Zeit - trotzdem neugierig? Hier ist Euer Podcast Update für alles, was Ihr zu aktueller Forschung wissen müsst. Kurz, relevant und überraschend. Die Themen in dieser Podcast-Folge: (00:00:26) Weltrekord für durchsichtige Solarzellen (00:03:18) Jodelnde Affen. Unsere große IQ-Umfrage 2025 ist vorbei. Vielen Dank an alle, die mitgemacht haben! Wir freuen uns, von Euch zu hören: WhatsApp (https://wa.me/491746744240) oder iq@br.de.

#203 Wie Türsteher entscheiden, wer in den Club darf - und wer nicht | Diese KI spricht eure Gedanken aus!
Wenig Zeit - trotzdem neugierig? Hier ist Euer Podcast Update für alles, was Ihr zu aktueller Forschung wissen müsst. Kurz, relevant und überraschend. Die Themen in dieser Podcast-Folge: (00:00:24) KI verwandelt Gedanken in Sprache (00:03:15) Wie Türsteher entscheiden, wer in den Club darf. Unsere große IQ-Umfrage 2025 ist vorbei. Vielen Dank an alle, die mitgemacht haben! Wir freuen uns, von Euch zu hören: WhatsApp (https://wa.me/491746744240) oder iq@br.de.

#202 Der Baum, der Blitze anzieht | Die Wespe mit der Venusfliegenfalle | Gänsestopfleber ohne Gänsestopfen
Wenig Zeit - trotzdem neugierig? Hier ist Euer Podcast Update für alles, was Ihr zu aktueller Forschung wissen müsst. Kurz, relevant und überraschend. Die Themen in dieser Podcast-Folge: (00:00:25) Die Wespe mit der Venusfliegenfalle (00:02:15) Gänsestopfleber ohne Gänsestopfen (00:04:50) Der Baum, der Blitze anzieht Unsere große IQ-Umfrage 2025 ist vorbei. Vielen Dank an alle, die mitgemacht haben! Wir freuen uns, von Euch zu hören: WhatsApp (https://wa.me/491746744240) oder iq@br.de

#201 Videokonferenzen: der Ton ist wichtig! | Ewigkeitschemikalien PFAS: so kann man sie zerstören
Wenig Zeit - trotzdem neugierig? Hier ist Euer Podcast Update für alles, was Ihr zu aktueller Forschung wissen müsst. Kurz, relevant und überraschend. Die Themen in dieser Podcast-Folge: (00:00:21) Ewigkeitschemikalien PFAS: so kann man sie zerstören (00:04:09) Videokonferenzen: so wichtig ist die Tonqualität Wir freuen uns, von Euch zu hören: WhatsApp (https://wa.me/491746744240) oder iq@br.de

#200 Wenn der Weiße Hai als Raubtier fehlt | E-Scooternutzer fahren unvorsichtiger als andere Verkehrsteilnehmer
Wenig Zeit - trotzdem neugierig? Hier ist Euer Podcast Update für alles, was Ihr zu aktueller Forschung wissen müsst. Kurz, relevant und überraschend. Die Themen in dieser Podcast-Folge: (00:00:46) Wenn der Weiße Hai als Raubtier fehlt (00:04:50) E-Scooter-Nutzer fahren unvorsichtiger als andere Verkehrsteilnehmer Wir freuen uns, von Euch zu hören: WhatsApp (https://wa.me/491746744240) oder iq@br.de

#199 Marathonläufer verlieren Fett im Gehirn | Tuberkulose wird wieder gefährlicher | Robben messen Sauerstoff im eigenen Blut
Wenig Zeit - trotzdem neugierig? Hier ist Euer Podcast Update für alles, was Ihr zu aktueller Forschung wissen müsst. Kurz, relevant und überraschend. Die Themen in dieser Podcast-Folge: (00:00:20) Marathonläufer verlieren Fett im Gehirn Reversible reduction in brain myelin content upon marathon running (00:02:26) Tuberkulose wird gefährlicher WHO calls for urgent action to address worldwide disruptions in tuberculosis services putting millions of lives at risk (00:04:25) Robben messen Sauerstoff m eigenen Blut Cognitive perception of circulating oxygen in seals is the reason they don't drown Unsere große IQ-Umfrage 2025 ist vorbei. Vielen Dank an alle, die mitgemacht haben! Wir freuen uns, von Euch zu hören: WhatsApp (https://wa.me/491746744240) oder iq@br.de

#198 Smartphones - Deswegen erzeugen sie Stress bei Jugendlichen | Richtig angepflanzt - So retten Bäume Leben? | Fußball - Vereine vergeuden Millionen beim Nachwuchs
Wenig Zeit - trotzdem neugierig? Hier ist Euer Podcast Update für alles, was Ihr zu aktueller Forschung wissen müsst. Kurz, relevant und überraschend. Die Themen in dieser Podcast-Folge: (00:00:45) Bäume in Gruppen oder alleine angepflanzt - Gut für die Gesundheit? https://www.thelancet.com/journals/lanplh/article/PIIS2542-5196(25)00022-1/fulltext | (00:03:40) Smartphones - Deswegen erzeugen sie Stress bei Jugendlichen https://www.frontiersin.org/journals/digital-health/articles/10.3389/fdgth.2025.1497222/full | (00:05:54) Fußball - Deswegen werden wichtige Talente übersehen! - Außer beim FC Bayern und Bayer Leverkusen https://www.rfberlin.com/wp-content/uploads/2025/03/Tohoff-Mechtel-JSE-accepted-paper.pdf | Wir freuen uns, von Euch zu hören: WhatsApp (https://wa.me/491746744240) oder iq@br.de

#197 Gute Nachricht gesucht - Viele Klima-Rekorde 2024 | Mit diesem Trick werden Lebensmittel gesünder
Wenig Zeit - trotzdem neugierig? Hier ist Euer Podcast Update für alles, was Ihr zu aktueller Forschung wissen müsst. Kurz, relevant und überraschend. Die Themen in dieser Podcast-Folge: (00:00:44) Neue Klimarekorde - viele negativ (00:03:35) Arm oder reich - Wer will was für's Klima tun? (00:04:59) Mit diesem Trick werden Lebensmittel gesünder | Wir freuen uns, von Euch zu hören: WhatsApp (https://wa.me/491746744240) oder iq@br.de

#196 Tier-Spezial: Der Wolf ist zurück bei uns - Über 22.000 | Dieser Leguan hat Seefahrer-Qualitäten
Wenig Zeit - trotzdem neugierig? Hier ist Euer Podcast Update für alles, was Ihr zu aktueller Forschung wissen müsst. Kurz, relevant und überraschend. Die Themen in dieser Podcast-Folge: (00:00:37) Zahl der Wölfe steigt auf über 22.000 https://journals.plos.org/sustainabilitytransformation/article?id=10.1371/journal.pstr.0000158&utm_source=pr&utm_medium=email&utm_campaign=plos006#sec007 (00:03:52) Leguan mit Seefahrer-Qualitäten erreicht Fidschi Inseln https://www.pnas.org/doi/10.1073/pnas.2318622122 | Wir freuen uns, von Euch zu hören: WhatsApp (https://wa.me/491746744240) oder iq@br.de

#195 Diesen Zahn-Rekord haben wir alle geschafft! | Darum werden Vegetarier angefeindet
Wenig Zeit - trotzdem neugierig? Hier ist Euer Podcast Update für alles, was Ihr zu aktueller Forschung wissen müsst. Kurz, relevant und überraschend. Die Themen in dieser Podcast-Folge: (00:00:47) Aggression gegen Vegetarier - Warum? Darum! https://www.sciencedirect.com/science/article/pii/S0950329324002829 (00:04:05) Zahn-Rekord - So gesund sind unsere Zähne! http://www.deutsche-mundgesundheitsstudie.de/ Wir freuen uns, von Euch zu hören: WhatsApp (https://wa.me/491746744240) oder iq@br.de

#194 SphereX - Dieses Weltraumteleskop soll Universum kartografieren | Pestizide sind fast überall
Wenig Zeit - trotzdem neugierig? Hier ist Euer Podcast Update für alles, was Ihr zu aktueller Forschung wissen müsst. Kurz, relevant und überraschend. Die Themen in dieser Podcast-Folge: (00:00:21) Weltraumteleskop SphereX soll Universum kartografieren. https://www.jpl.nasa.gov/missions/spherex/ (00:02:17) Pestizide sind überall https://www.nature.com/articles/s41598-024-84811-4 Wir freuen uns, von Euch zu hören: WhatsApp (https://wa.me/491746744240) oder iq@br.de

#193 Diese Supernova hat ein Massenaussterben ausgelöst | Dein Händeklatschen ist unverwechselbar | Naturvideos lindern Schmerzen |
Wenig Zeit - trotzdem neugierig? Hier ist Euer Podcast Update für alles, was Ihr zu aktueller Forschung wissen müsst. Kurz, relevant und überraschend. Die Themen in dieser Podcast-Folge: (00:00:25) Händeklatschen ist unverwechselbar (00:01:50) Naturvideos lindern Schmerzen (00:04:02) Supernova hat Massenaussterben ausgelöst. Wir freuen uns, von Euch zu hören: WhatsApp (https://wa.me/491746744240) oder iq@br.de

#192 So schützt Schlaf vor Erkältung | Mikroplastik macht Bakterien gefährlicher | Mögliche künftige Alternative zur Abnehmspritze Ozempic
Wenig Zeit - trotzdem neugierig? Hier ist Euer Podcast Update für alles, was Ihr zu aktueller Forschung wissen müsst. Kurz, relevant und überraschend. Die Themen in dieser Podcast-Folge: (00:00:22) Mikroplastik macht Bakterien gefährlicher (00:01:57) Mögliche Alternative zur Abnehmspritze (00:04:01) Schlaf schützt vor Erkältung. Wir freuen uns, von Euch zu hören: WhatsApp (https://wa.me/491746744240) oder iq@br.de

#191 Germany's Next Top Model - Ungewollte Nebenwirkungen | Kohlmeisen verändern Gesangsmuster | Eis auf dem Mond |
Wenig Zeit - trotzdem neugierig? Hier ist Euer Podcast Update für alles, was Ihr zu aktueller Forschung wissen müsst. Kurz, relevant und überraschend. Die Themen in dieser Podcast-Folge: (00:00:26) Kohlmeisen verändern Gesangsmuster https://www.cell.com/current-biology/fulltext/S0960-9822(25)00150-2 (00:02:34) Eis auf dem Mond https://www.nature.com/articles/s43247-025-02114-6 (00:04:32) Die Nebenwirkungen von Germany's Next Top Model https://onlinelibrary.wiley.com/doi/full/10.1002/erv.3185 Wir freuen uns, von Euch zu hören: WhatsApp (https://wa.me/491746744240) oder iq@br.de

Das ist der älteste Meteoritenkrater der Erde | Vögel bauen Nester aus Plastik | Spirituelle Langeweile
Wenig Zeit - trotzdem neugierig? Hier ist Euer Podcast Update für alles, was Ihr zu aktueller Forschung wissen müsst. Kurz, relevant und überraschend. Die Themen in dieser Podcast-Folge: (00:00:30) Ältester Meteoritenkrater entdeckt A Paleoarchaean impact crater in the Pilbara Craton, Western Australia https://www.nature.com/articles/s41467-025-57558-3 (00:03:05) Vögel bauen Nester aus Plastik https://esajournals.onlinelibrary.wiley.com/doi/full/10.1002/ecy.70010 (00:04:54) Spirituelle Langeweile. https://www.nature.com/articles/s44271-025-00216-7 Wir freuen uns, von Euch zu hören: WhatsApp (https://wa.me/491746744240) oder iq@br.de.

#189 Gute Nachrichten aus dem schrumpfenden Ozonloch | Zigarettenkippen sind Bakterienschleudern | Der problematische Speiseplan der Asiatischen Hornisse
Wenig Zeit - trotzdem neugierig? Hier ist Euer Podcast Update für alles, was Ihr zu aktueller Forschung wissen müsst. Kurz, relevant und überraschend. Die Themen in dieser Podcast-Folge: (00:00:20) Das Ozonloch schrumpft dank uns https://www.nature.com/articles/s41586-025-08640-9 (00:02:21) Zigarettenkippen sind Bakterienschleudern https://ehp.niehs.nih.gov/doi/10.1289/EHP14704 (00:03:48) Die Asiatische Hornisse is(s)t ein Problem. https://www.sciencedirect.com/science/article/pii/S0048969725006138?via%3Dihub Wir freuen uns, von Euch zu hören: WhatsApp (https://wa.me/491746744240) oder iq@br.de.

#188 Wollhaarmaus: Eine Maus mit Mammutfell | Narwale nutzen ihren Stoßzahn zur Jagd
Wenig Zeit - trotzdem neugierig? Hier ist Euer Podcast Update für alles, was Ihr zu aktueller Forschung wissen müsst. Kurz, relevant und überraschend. Die Themen in dieser Podcast-Folge: (00:00:27) Maus mit Mammutfell https://www.biorxiv.org/content/10.1101/2025.03.03.641227v1 (00:03:58) Narwale nutzen ihren Stoßzahn zur Jagd. https://www.frontiersin.org/journals/marine-science/articles/10.3389/fmars.2025.1518605/full Wir freuen uns, von Euch zu hören: WhatsApp (https://wa.me/491746744240) oder iq@br.de.

#187 Ein Gehirn aus Glas | Ein Stonehenge aus Holz | Ein Schmetterling in Bernstein
Wenig Zeit - trotzdem neugierig? Hier ist Euer Podcast Update für alles, was Ihr zu aktueller Forschung wissen müsst. Kurz, relevant und überraschend. Die Themen in dieser Podcast-Folge: (00:00:31) Ein Gehirn aus Glas (00:02:58) Eine Art Stonehenge aus Holz (00:04:33) Ein Schmetterling in Bernstein. Wir freuen uns, von Euch zu hören: WhatsApp (https://wa.me/491746744240) oder iq@br.de.

#186 Kurzsichtig - So viel Zeit am Bildschirm erhöht das Risiko | Warum ist der Mars wirklich rot? | Munition vergiftet die Ostsee
Wenig Zeit - trotzdem neugierig? Hier ist Euer Podcast Update für alles, was Ihr zu aktueller Forschung wissen müsst. Kurz, relevant und überraschend. Die Themen in dieser Podcast-Folge: (00:00:45) Munition vergiftet Ostsee (00:02:37) Je mehr Zeit am Bildschirm, desto höher das Risiko für Kurzsichtigkeit(00:04:15) Warum ist der Mars wirklicklich rot?Wir freuen uns über Post von euch! Ihr erreicht uns per Whatsapp oder Email: iq@br.de

#185 Golfstrom - Wann bricht er zusammen? | Klimaschutz im Operationssaal
Wenig Zeit - trotzdem neugierig? Hier ist Euer Podcast Update für alles, was Ihr zu aktueller Forschung wissen müsst. Kurz, relevant und überraschend. Die Themen in dieser Podcast-Folge: (00:00:36) Bricht der Golfstrom zusammen, wenn wir so weitermachen? https://www.nature.com/articles/s41586-024-08544-0 (00:04:44) Klimaschutz im OP - mit der richtigen Anästhesie https://journals.lww.com/anesthesia-analgesia/fulltext/9900/the_power_of_education_to_reduce_t he_carbon.1194.aspx | Wir freuen uns, von Euch zu hören: WhatsApp (https://wa.me/491746744240) oder iq@br.de.

Das ist die weiteste Reise des Universums
Trailer Habt Ihr Lust, echt weit weg zu kommen? Auf einen wirklich wilden Ritt? Zum entferntesten Punkt, den wir überhaupt erreichen können? Dann steigt ein: zur Weitesten Reise des Universums. In diesem 2-teiligen Podcast beantworten wir die Frage: weit können wir danke Wissenschaft und Technik überhaupt reisen? Wenn wir von der Erde losziehen - Richtung All - und erst anhalten, wenn es einfach nicht mehr weitergeht. Bitte hier Einsteigen: es geht los in 3, 2, 1 .... Teil1: Die weiteste Reise (1) - Ins Universum https://1.ard.de/WeitesteReise1 Teil2: Die weiteste Reise (2) - Bis zur letzten Grenze https://1.ard.de/WeitesteReise2 Ein Podcast von Stefan Geier. Habt Ihr Feedback? Anregungen? Wir freuen uns, von Euch zu hören: WhatsApp (https://wa.me/491746744240) oder iq@br.de Falls Euch der IQ-Podcast gefällt, freuen wir uns über eine gute Bewertung, einen freundlichen Kommentar und ein Abo. Und wenn Ihr unseren Podcast unterstützen wollt, empfehlt uns gerne weiter! IQ verpasst? Hier könnt Ihr die letzten Folgen hören: https://1.ard.de/IQWissenschaft

#184 Asteroid YR4 verpasst die Erde? | Intelligenz mach sexy - Bei Fischen | Hunnen waren auch Europäer
Wenig Zeit - trotzdem neugierig? Hier ist Euer Podcast Update für alles, was Ihr zu aktueller Forschung wissen müsst. Kurz, relevant und überraschend. Die Themen in dieser Podcast-Folge: (00:00:46) Asteroid YR4 verpasst wohl doch die Erde https://cneos.jpl.nasa.gov/sentry/details.html#?des=2024%20YR4 (00:02:20) Hunnen waren auch Europäer https://www.pnas.org/cgi/doi/10.1073/pnas.2418485122 (00:03:42) Intelligente Fische sind sexy https://www.nature.com/articles/s41559-025-02645-3 Wir freuen uns über Post von euch! Ihr erreicht uns per Whatsapp oder Email: iq@br.de

#183 Nachtisch geht immer! - So funktioniert unser Dessert-Magen | Wölfe sind gut fürs Klima | Wunderbaum, Raumspray, Putzmittel verschmutzen unsere Luft
Wenig Zeit - trotzdem neugierig? Hier ist Euer Podcast Update für alles, was Ihr zu aktueller Forschung wissen müsst. Kurz, relevant und überraschend. Die Themen in dieser Podcast-Folge: (00:01:00) Wölfe sind gut fürs Klima https://besjournals.onlinelibrary.wiley.com/doi/10.1002/2688-8319.70016 | (00:02:54) So funktioniert der Dessert-Magen https://www.mpg.de/24158273/0211-neur-dessertmagen-entsteht-im-gehirn-153735-x?c=2191 | (00:04:27) So gefährlich sind parfümierte Gebrauchsmittel https://www.eurekalert.org/news-releases/1073770 | Wir freuen uns, von Euch zu hören: WhatsApp (https://wa.me/491746744240) oder iq@br.de.

#182 Unser Herz kann Zucker schmecken | Monsterwellen vor Norderney | Affen und Menschen produzieren Werkzeuge nur zufällig?
Wenig Zeit - trotzdem neugierig? Hier ist Euer Podcast Update für alles, was Ihr zu aktueller Forschung wissen müsst. Kurz, relevant und überraschend. Die Themen in dieser Podcast-Folge: (00:01:21) Unser Herz schmeckt Zucker https://www.biophysics.org/news-room/sweet-taste-receptors-in-the-heart-a-new-pathway-for-cardiac-regulation | (00:03:00) Affen produzieren erste Werkzeuge - aus Zufall? https://www.pnas.org/doi/full/10.1073/pnas.2420067122 | (00:04:38) Monsterwellen in der Nordsee/Norderney https://www.bsh.de/SharedDocs/Pressemitteilungen/DE/Text_html/html_2025/Pressemitteilung-2025-19-02.html | Wir freuen uns, von Euch zu hören: WhatsApp (https://wa.me/491746744240) oder iq@br.de.

#181 Sexualstraftäter finden - Mit Bakterien statt DNA - Sexiom als Werkzeug für die Spurensicherung
Wenig Zeit - trotzdem neugierig? Hier ist Euer Podcast Update für alles, was Ihr zu aktueller Forschung wissen müsst. Kurz, relevant und überraschend. Das Thema in dieser Podcast-Folge: Suche nach Sexualstraftätern - Bakterien statt DNA - Hilfe für die Spurensicherung https://www.cell.com/iscience/fulltext/S2589-0042(25)00121-X Das Hilfetelefon "Gewalt gegen Frauen" ist ein bundesweites Beratungsangebot für Frauen, die Gewalt erlebt haben oder noch erleben, die Nummer: 116 016 https://www.hilfetelefon.de Wir freuen uns, von Euch zu hören: WhatsApp (https://wa.me/491746744240) oder iq@br.de.
#180 Müffeln Mumien? - Oder duften sie? | Intervallfasten - bedenklich für Jugendliche | Nemos Geheimnis - Superkraft von Clownfisch entdeckt
Wenig Zeit - trotzdem neugierig? Hier ist Euer Podcast Update für alles, was Ihr zu aktueller Forschung wissen müsst. Kurz, relevant und überraschend. Die Themen in dieser Podcast-Folge: (00:00:51) So müffeln Mumien - Oder duften? https://pubs.acs.org/doi/10.1021/jacs.4c15769 | (00:02:36) Intervallfasten - Nichts für Kinder und Jugendliche https:/www.cell.com/cell-reports/fulltext/S2211-1247(24)01576-6 (00:03:58) Nemos Superkraft - Wie man dem Gift von Nesseln widersteht https://bmcbiol.biomedcentral.com/articles/10.1186/s12915-025-02144-8 Wir freuen uns, von Euch zu hören: WhatsApp (https://wa.me/491746744240) oder iq@br.de. Unsere Podcast Empfehlung Hier geht's zu den Geschichten von Telephobia - Dieser eine Anruf: https://1.ard.de/wissenschaft-telephobia3

#179 Experiment: Kann der Affe das? - Bonbobos sollen sich in Menschen hinein versetzen
Wenig Zeit - trotzdem neugierig? Hier ist Euer Podcast Update für alles, was Ihr zu aktueller Forschung wissen müsst. Kurz, relevant und überraschend. Das Thema in dieser Podcast-Folge: Können sich Bonobos in andere (Menschen) hinein versetzen? - Wissen über andere bei Menschenaffen getestet https://www.pnas.org/doi/full/10.1073/pnas.2412450122 Wir freuen uns, von Euch zu hören: WhatsApp (https://wa.me/491746744240) oder iq@br.de. Hier geht's lang zu "Sparks - Menschen, die uns inspirieren" https://1.ard.de/sparks?cp=wiss

#178 Vergiftete Hundehaare bedrohen Vogel-Küken - So können wir Küken schützen
Wenig Zeit - trotzdem neugierig? Hier ist Euer Podcast Update für alles, was Ihr zu aktueller Forschung wissen müsst. Kurz, relevant und überraschend. Das Thema in dieser Podcast-Folge: (00:00:18) Vergiftete Hundehaare bedrohen Küken Wir freuen uns, von Euch zu hören: WhatsApp (https://wa.me/491746744240) oder iq@br.de.

#177 Dieser Reis erzeugt 70% weniger Methan | Klimafreundlicher Reis
Wenig Zeit - trotzdem neugierig? Hier ist Euer Podcast Update für alles, was Ihr zu aktueller Forschung wissen müsst. Kurz, relevant und überraschend. Das Thema in dieser Podcast-Folge: (00:00:18) Neue Reissorte erzeugt 70 Prozent weniger Methan. Wir freuen uns, von Euch zu hören: WhatsApp (https://wa.me/491746744240) oder iq@br.de.

#176 So flirten Schimpansen - in Dialekten | Klimaextreme im 16. Jahrhundert entschlüsselt
Wenig Zeit - trotzdem neugierig? Hier ist Euer Podcast Update für alles, was Ihr zu aktueller Forschung wissen müsst. Kurz, relevant und überraschend. Die Themen in dieser Podcast-Folge: (00:00:18) Schimpansenmännchen flirten in unterschiedlichen Dialekten (00:03.22) Klimaextreme im 16. Jahrhundert. Wir freuen uns, von Euch zu hören: WhatsApp (https://wa.me/491746744240) oder iq@br.de.

#175 Zombiespinne entdeckt? | Papyrusrollen aus Pompeij entziffert | Feinstaub verlängert Schwangerschaft
Wenig Zeit - trotzdem neugierig? Hier ist Euer Podcast Update für alles, was Ihr zu aktueller Forschung wissen müsst. Kurz, relevant und überraschend. Die Themen in dieser Podcast-Folge: (00:00:22) Feinstaub und Hitze verlängern Schwangerschaften (00:02:45) Was auf verkohlten Papyrusrollen aus Pompeij steht (00:04:36) Pilze verwandeln Spinnen in Zombies. Wir freuen uns, von Euch zu hören: WhatsApp (https://wa.me/491746744240) oder iq@br.de.

#174 Spendernieren von Schweinen | Gibt's in 75 Jahren noch Eis am Nordpol | Das luftige Jagdrevier der Faltlippenbulldogfledermaus
Wenig Zeit - trotzdem neugierig? Hier ist Euer Podcast Update für alles, was Ihr zu aktueller Forschung wissen müsst. Kurz, relevant und überraschend. Die Themen in dieser Podcast-Folge: (00:00:32) Spendernieren von Schweinen (00:03:08) Gibt es in 75 Jahren noch Eis am Nordpol (00:05:27) Die Faltlippenbulldogfledermaus jagt in schwindelerregenden Höhen. Wir freuen uns über Post von euch! Ihr erreicht uns per Whatsapp oder Email: iq@br.de

#173 Wetterphänomen - La Niña hat begonnen | Wir stecken mittendrin
Wenig Zeit - trotzdem neugierig? Hier ist Euer Podcast Update für alles, was Ihr zu aktueller Forschung wissen müsst. Kurz, relevant und überraschend. Das Thema in dieser Podcast-Folge: Wetterphänomen - La Niña hat begonnen - Wir stecken mittendrin | https://www.cpc.ncep.noaa.gov/products/analysis_monitoring/enso_advisory/ensodisc.shtml Habt Ihr Feedback? Anregungen? Wir freuen uns, von Euch zu hören: WhatsApp oder iq@br.de

#172 Was haben die Römer je für uns getan? | So kocht ihr das perfekte Ei | Warum wir uns nicht selbst kitzeln können
Wenig Zeit - trotzdem neugierig? Hier ist Euer Podcast Update für alles, was Ihr zu aktueller Forschung wissen müsst. Kurz, relevant und überraschend. Die Themen in dieser Podcast-Folge: (00:00:30) Was haben die Römer je für uns getan? (00:04:12) Anleitung für perfekt gekochte Eier (00:05:46) Warum wir uns nicht selbst kitzeln können. Wir freuen uns, von Euch zu hören: WhatsApp (https://wa.me/491746744240) oder iq@br.de.

#171 Der Morgen ist die allerbeste Tageszeit! | Welche Fragen sind zu schwer für die KI? | 1,3 als magische Zahl für Straßenverbindungen
Wenig Zeit - trotzdem neugierig? Hier ist Euer Podcast Update für alles, was Ihr zu aktueller Forschung wissen müsst. Kurz, relevant und überraschend. Die Themen in dieser Podcast-Folge: (00:00:34) Wohlbefinden hängt von der Tageszeit ab (00:02:58) KI vs. Letzte Prüfung der Menschheit (00:05:13) 1,3 als magische Zahl für Straßenverbindungen. Wir freuen uns, von Euch zu hören: WhatsApp (https://wa.me/491746744240) oder iq@br.de.

Spezial: Krebsrisiko senken? - Blick in den Spiegel! | Das verrät unsere Taille über unsichtbares Bauchfett
Wenig Zeit - trotzdem neugierig? Hier ist Euer Podcast Update für alles, was Ihr zu aktueller Forschung wissen müsst. Kurz, relevant und überraschend. Das Thema in dieser Podcast-Folge: Kann man mit einem Blick in den Spiegel das Krebsrisiko ablesen? - Was verrät unsere Taille über unsichtbares Bauchfett? Schlanke Taille und ausreichend Bewegung - Erst die Kombination senkt das Krebsrisiko deutlich https://pubmed.ncbi.nlm.nih.gov/39843229/ | BMI Rechner: https://www.tk.de/service/app/2002866/bmirechner/bmirechner.app | WHR Rechner: https://www.bkk24.de/lbl/ratgeber-gesundheit/artikel-lesen/whr-rechner.html | Habt Ihr Feedback? Anregungen? Wir freuen uns, von Euch zu hören: WhatsApp oder iq@br.de

#170 Wie uns Fisch und Walnüsse verjüngen | Wie viel Mikroplastik sammelt sich im Gehirn an?
Wenig Zeit - trotzdem neugierig? Hier ist Euer Podcast Update für alles, was Ihr zu aktueller Forschung wissen müsst. Kurz, relevant und überraschend. Die Themen in dieser Podcast-Folge: (00:00:24) Wieviel Mikroplastik finden wir in menschlichen Gehirnen? Mehr zur Frage, wie gefährlich Mikroplastik im Gehirn ist, gibt es in dieser Folge von IQ - Wissenschaft und Forschung: https://www.ardaudiothek.de/episode/iq-wissenschaft-und-forschung/mikroplastik-im-gehirn-wie-gefaehrlich-ist-es/bayern-2/14153419/ (00:03:11) Wie uns Omega-3-Fettsäuren jünger machen. Wir freuen uns, von Euch zu hören: WhatsApp (https://wa.me/491746744240) oder iq@br.de.

#167 So beeinflusst Cannabis unsere Gehirnleistung | Die ersten Menschen in Europa waren ...? | Erstaunlicher Reise-Trick von Pflanzenmilben
Wenig Zeit - trotzdem neugierig? Hier ist Euer Podcast Update für alles, was Ihr zu aktueller Forschung wissen müsst. Kurz, relevant und überraschend. Die Themen in dieser Podcast-Folge: (00:00:45) Wie beeinflusst Cannabis das Gedächtnis? https://shorturl.at/W3PTx | (00:02:38) Die ersten Menschen in Europa waren ...? https://www.nature.com/articles/s41467-025-56154-9 | (00:04:16) Diese Pflanzen-Milben reisen elektrisch https://www.pnas.org/doi/full/10.1073/pnas.2419214122 (mit Videos) | Hier geht es zum Sternenhimmel im Februar, der Folge mit Franzi Konitzer: Winter-Sternenhimmel - Jetzt schon den Frühling sehen! https://www.ardaudiothek.de/episode/iq-wissenschaft-und-forschung/winter-sternenhimmel-jetzt-schon-den-fruehling-sehen/bayern-2/14138441/ Wir freuen uns, von Euch zu hören: WhatsApp (https://wa.me/491746744240) oder iq@br.de.

#169 Dieser Asteroid steuert auf die Erde zu | Dieses Pflaster kommt direkt auf's Herz | Kaffee schmeckt nur mit dem richtigen Erbgut
Wenig Zeit - trotzdem neugierig? Hier ist Euer Podcast Update für alles, was Ihr zu aktueller Forschung wissen müsst. Kurz, relevant und überraschend. Die Themen in dieser Podcast-Folge: (00:00:33) Dieses Pflaster kommt direkt auf's Herz https://pubmed.ncbi.nlm.nih.gov/39880949/ | (00:02:45) Kaffee schmeckt nur mit dem richtigen Erbgut https://www.sciencedirect.com/science/article/pii/S0308814624041979?via%3Dihub | (00:04:55) Asteroid 2024 YR4 steuert auf die Erde zu https://www.esa.int/Space_Safety/Planetary_Defence/ESA_actively_monitoring_near-Earth_asteroid_2024_YR4 | Wir freuen uns, von Euch zu hören: WhatsApp (https://wa.me/491746744240) oder iq@br.de.

#168 Post vom Asteroiden - War auf Bennu Leben möglich? | Klimawandel hat Waldbrände begünstigt | Mitmachaktion: Artenolympiade
Wenig Zeit - trotzdem neugierig? Hier ist Euer Podcast Update für alles, was Ihr zu aktueller Forschung wissen müsst. Kurz, relevant und überraschend. Die Themen in dieser Podcast-Folge: (00:00:34) Nachrichten vom Asteroiden - Leben möglich? | https://www.nature.com/articles/s41550-024-02472-9 https://www.nature.com/articles/s41586-024-08495-6 (00:02:30) Klimawandel hat Waldbrände begünstigt | https://www.worldweatherattribution.org/climate-change-increased-the-likelihood-of-wildfire-disaster-in-highly-exposed-los-angeles-area/ (00:04:20) Mitmachen erwünscht: Artenolympiade Hier ist der Link zum Mitmachen: https://observation.org/ Wir freuen uns, von Euch zu hören: WhatsApp (https://wa.me/491746744240) oder iq@br.de.

#166 Der größte Eisberg ist auf Kollisionskurs | Mit diesen Algen könnte man Flüsse sauber machen
Wenig Zeit - trotzdem neugierig? Hier ist Euer Podcast Update für alles, was Ihr zu aktueller Forschung wissen müsst. Kurz, relevant und überraschend. Die Themen in dieser Podcast-Folge: (00:00:40) Kieselalgen zur Flussreinigung https://onlinelibrary.wiley.com/doi/10.1002/adsu.202400776 | (00:03:23) Eisberg auf Kollisionskurs https://www.bbc.com/news/articles/cd64vvg4z6go | Wir freuen uns, von Euch zu hören: WhatsApp (https://wa.me/491746744240) oder iq@br.de.

#165 Lieblingskind? Mädchen! | Schlank oder krank mit der Abnehmspritze? | Wellness Anlage der Römer entdeckt
Wenig Zeit - trotzdem neugierig? Hier ist Euer Podcast Update für alles, was Ihr zu aktueller Forschung wissen müsst. Kurz, relevant und überraschend. Die Themen in dieser Podcast-Folge: (00:00:31) Schlank oder krank mit der Abnehmspritze? (00:02:35) Lieblingskind? Mädchen! (00:04:07) Wellness-Anlage der Römer entdeckt! Wir freuen uns, von Euch zu hören: WhatsApp (https://wa.me/491746744240) oder iq@br.de.

#164 Paleo Diät entzaubert? - Was aßen unsere frühen Vorfahren?
Wenig Zeit - trotzdem neugierig? Hier ist Euer Podcast Update für alles, was Ihr zu aktueller Forschung wissen müsst. Kurz, relevant und überraschend. Das Thema in dieser Podcast-Folge: Paleo Diät entzaubert? Was aßen unsere frühen Vorfahren? | https://www.science.org/doi/abs/10.1126/science.Adq7315 Habt Ihr Feedback? Anregungen? Wir freuen uns, von Euch zu hören: WhatsApp oder iq@br.de

#163 Männer 4cm, Frauen 1,7cm - wir werden immer größer! | Mikroplastik wandert ins Gehirn | Schimpansen gehen auch gemeinsam auf's Klo
Wenig Zeit - trotzdem neugierig? Hier ist Euer Podcast Update für alles, was Ihr zu aktueller Forschung wissen müsst. Kurz, relevant und überraschend. Die Themen in dieser Podcast-Folge: (00:00:43) Wir werden immer größer | https://royalsocietypublishing.org/doi/10.1098/rsbl.2024.0565 (00:02:22) Mikroplastik wandert ins Gehirn | https://www.science.org/doi/10.1126/sciadv.adr8243 (00:04:27) Schimpansen gehen auch gemeinsam auf's Klo https://www.cell.com/current-biology/fulltext/S0960-9822(24)01594-X?utm_medium=homepage | Wir freuen uns, von Euch zu hören: WhatsApp (https://wa.me/491746744240) oder iq@br.de.

#162 Seltene Planetenparade - So könnt Ihr sie sehen! | Kaninchen essen ihre eigenen Zähne | Kalorienangaben machen uns nicht gesünder |
Wenig Zeit - trotzdem neugierig? Hier ist Euer Podcast Update für alles, was Ihr zu aktueller Forschung wissen müsst. Kurz, relevant und überraschend. Die Themen in dieser Podcast-Folge: (00:00:46) Kalorienangaben machen uns nicht gesünder https://www.cochranelibrary.com/cdsr/doi/10.1002/14651858.CD014845.pub2/full/de | (00:03:00) Kaninchen essen ihre eigenen Zähne https://www.sciencedirect.com/science/article/pii/S1090023324002077 | (00:04:13) Seltene Planetenparade: 6 Planeten sind gleichzeitig am Himmel zu sehen | Wir freuen uns, von Euch zu hören: WhatsApp (https://wa.me/491746744240) oder iq@br.de.

#161 Eiskalter Rekord: Der längste Eisbohrkern der Welt - Wird jetzt das größte Klima-Rätsel gelöst?
Wenig Zeit - trotzdem neugierig? Hier ist Euer Podcast Update für alles, was Ihr zu aktueller Forschung wissen müsst. Kurz, relevant und überraschend. Das Thema in dieser Podcast-Folge: Der längste Eisbohrkern aus der Antarktis - Ein Blick in Millionen Jahre Klimageschichte https://www.awi.de/ueber-uns/service/presse/presse-detailansicht/mehr-als-12-millionen-jahre-altes-eis-erbohrt.html | Habt Ihr Feedback? Anregungen? Wir freuen uns, von Euch zu hören: WhatsApp oder iq@br.de

#160 Kelten in der Eisenzeit: Frauen hatten die Macht | Rotes Fleisch lässt euer Gehirn altern | Wie Mähroboter igelsicher werden sollen
Wenig Zeit - trotzdem neugierig? Hier ist Euer Podcast Update für alles, was Ihr zu aktueller Forschung wissen müsst. Kurz, relevant und überraschend. Die Themen in dieser Podcast-Folge: (00:00:30) Kelten in der Eisenzeit: Frauen im Zentrum der Macht (00:03:04) Rotes Fleisch lässt euer Gehirn altern (00:05:18) Mähroboter vs. Igel. Wir freuen uns, von Euch zu hören: WhatsApp (https://wa.me/491746744240) oder iq@br.de.

#159 Bitte recht freundlich: Neue Dino-Art entdeckt - per Foto! | Warnung vor Herzenskälte bei Minusgraden
Wenig Zeit - trotzdem neugierig? Hier ist Euer Podcast Update für alles, was Ihr zu aktueller Forschung wissen müsst. Kurz, relevant und überraschend. Die Themen in dieser Podcast-Folge: (00:00:32) Warnung vor Herzenskälte bei Minusgraden (00:03:04) Forschende entdecken neue Raubsaurier-Art - auf 80 Jahre alten Fotos. Wir freuen uns, von Euch zu hören: WhatsApp (https://wa.me/491746744240) oder iq@br.de.

#158 Wohin geht's auf der ältesten 3D-Karte der Welt? | Die jahrzehntelangen Folgen von Waldbränden | Fruchtfliegen haben den richtigen Riecher
Wenig Zeit - trotzdem neugierig? Hier ist Euer Podcast Update für alles, was Ihr zu aktueller Forschung wissen müsst. Kurz, relevant und überraschend. Die Themen in dieser Podcast-Folge: (00:00:41) Die jahrzehntelangen Folgen von Waldbränden https://doi.org/10.1029/2024AV001327 (00:03:14) Fruchtfliegen haben den richtigen Riecher https://journals.plos.org/plosone/article?id=10.1371/journal.pone.0295404 (00:05:49) Älteste 3D-Karte der Welt entdeckt. https://onlinelibrary.wiley.com/doi/10.1111/ojoa.12316 Wir freuen uns, von Euch zu hören: WhatsApp (https://wa.me/491746744240) oder iq@br.de.

#157 Die giftigste Spinne der Welt - mal drei! | Was die Augen über Depression verraten | Wie ihr auf Fleisch verzichten könnt, ohne es zu merken
Wenig Zeit - trotzdem neugierig? Hier ist Euer Podcast Update für alles, was Ihr zu aktueller Forschung wissen müsst. Kurz, relevant und überraschend. Die Themen in dieser Podcast-Folge: (00:00:38) Neuigkeiten von der giftigsten Spinne der Welt (00:03:35) Was die Augen über Depression verraten (00:05:24) Wie ihr auf Fleisch verzichten könnt, ohne es zu merken. Wir freuen uns, von Euch zu hören: WhatsApp (https://wa.me/491746744240) oder iq@br.de.

#156 Die Römer waren dümmer als nötig? | Bleivergiftung im Römischen Reich aus Eisbohrkernen nachgewiesen
Wenig Zeit - trotzdem neugierig? Hier ist Euer Podcast Update für alles, was Ihr zu aktueller Forschung wissen müsst. Kurz, relevant und überraschend. Das Thema in dieser Podcast-Folge: Die Römer waren dümmer als nötig? Kollektive Bleivergiftung im Römischen Reich aus Eisbohrkernen nachgewiesen https://www.pnas.org/doi/abs/10.1073/pnas.2419630121 | Habt Ihr Feedback? Anregungen? Wir freuen uns, von Euch zu hören: WhatsApp oder iq@br.de

#155 Sensationsfund: neue Art in Bayern entdeckt - Helodrilus Bavaricus | Vapen stoppen - Mit diesem Trick klappt es | Fluglärm erzeugt Herzprobleme
Wenig Zeit - trotzdem neugierig? Hier ist Euer Podcast Update für alles, was Ihr zu aktueller Forschung wissen müsst. Kurz, relevant und überraschend. Die Themen in dieser Podcast-Folge: (00:00:40) Vapen und Rauchen aufhören - mit diesem Trick klappt es| https://www.cochranelibrary.com/cdsr/doi/10.1002/14651858.CD016058.pub2/full (00:02:44) Fluglärm erzeugt Herzprobleme | https://www.sciencedirect.com/science/article/pii/S0735109724097973?via%3Dihub (00:04:02) Sensationsfund: neue Art in Bayern entdeckt - Helodrilus Bavaricus https://www.lfl.bayern.de/verschiedenes/presse/pms/2025/368470/index.php | Habt Ihr Feedback? Anregungen? Wir freuen uns, von Euch zu hören: WhatsApp oder iq@br.deSensationsfund: neue Art in Bayern entdeckt -

#153 Diese Fledermaus surft - über 1000km weit! | Großer Abendsegler, beim Langstrecken-Zug verfolgt
Wenig Zeit - trotzdem neugierig? Hier ist Euer Podcast Update für alles, was Ihr zu aktueller Forschung wissen müsst. Kurz, relevant und überraschend. Das Thema in dieser Podcast-Folge: Die große Abendsegler Fledermaus hat einen besonderen Trick entwickelt, um über 1000km weit zu fliegen - sie surft https://www.science.org/doi/10.1126/science.ade7441 | Habt Ihr Feedback? Anregungen? Wir freuen uns, von Euch zu hören: WhatsApp oder iq@br.de

#152 Viel älter als gedacht - Dieser Wal kann 150 werden | Inventur: Bedrohte Arten in Flüssen und Seen
Wenig Zeit - trotzdem neugierig? Hier ist Euer Podcast Update für alles, was Ihr zu aktueller Forschung wissen müsst. Kurz, relevant und überraschend. Die Themen in dieser Podcast-Folge: (00:00:49) Der Kaper-Wal kann viel älter werden als gedacht https://www.science.org/doi/10.1126/sciadv.adq3086 | (00:02:17) Wie bedroht sind die Arten in unseren Flüssen und Seen? https://www.nature.com/articles/s41586-024-08375-z | Habt Ihr Feedback? Anregungen? Wir freuen uns, von Euch zu hören: WhatsApp oder iq@br.de

#151 Das ist der perfekte Körper für Hula Hoop | Männern sind Liebesbeziehungen wichtiger als Frauen?
Wenig Zeit - trotzdem neugierig? Hier ist Euer Podcast Update für alles, was Ihr zu aktueller Forschung wissen müsst. Kurz, relevant und überraschend. Die Themen in dieser Podcast-Folge: (00:00:42) Romantische Beziehungen - Wem sind sie wichtiger, Männern oder Frauen? https://tinyurl.com/2xzts7yu | (00:03:02) Wie sieht der perfekte Hula Hoop Körper aus? https://www.pnas.org/doi/10.1073/pnas.2411588121 | Habt Ihr Feedback? Anregungen? Wir freuen uns, von Euch zu hören: WhatsApp oder iq@br.de

Rätsel um die Schlacht von Tollense - Die Früheste Kriegsführung in Mitteleuropa?
Lieblingspodcast / #1 Wenig Zeit - trotzdem neugierig? Hier ist Euer Podcast Update für alles, was Ihr zu aktueller Forschung wissen müsst. Kurz, relevant und überraschend. Das Thema in dieser Podcast-Folge: Rätsel um die Schlacht von Tollense gelöst? - Ist das der früheste Beleg für überregionale Kriegsführung in Mitteleuropa? https://shorturl.at/6ojhR | Habt Ihr Feedback? Anregungen? Wir freuen uns, von Euch zu hören: WhatsApp oder iq@br.de

Er hat die Dinosaurier auf dem Gewissen - Dino-Killer Asteroid ist im äußeren Sonnensystem entstanden | Massenaussterben
Lieblingspodcast 2024 / #2 Wenig Zeit - trotzdem neugierig? Hier ist Euer Podcast Update für alles, was Ihr zu aktueller Forschung wissen müsst. Kurz, relevant und überraschend. Das Thema in dieser Podcast-Folge: (00:00:18) Dinokiller-Asteroid ist im äußeren Sonnensystem entstanden. https://www.science.org/doi/10.1126/science.adk4868 Habt Ihr Feedback? Anregungen? Wir freuen uns, von Euch zu hören: WhatsApp oder iq@br.de

Auf dem Weg in den Tod ertönt dieses Geräusch - Bei den Azteken | Totenkopfpfeife nachgebaut und getestet
Lieblingspodcast 2024 | #3 Wenig Zeit - trotzdem neugierig? Hier ist Euer Podcast Update für alles, was Ihr zu aktueller Forschung wissen müsst. Kurz, relevant und überraschend. Das Thema in dieser Podcast-Folge: (00:00:38) Der Sound des Todes - Forscherteam baut Totenkopfpfeife der Azteken nach und testet die Wirkung | Hier findet Ihr die schaurigen Klänge der Aztekischen Totenkopfpfeife zum selber anhören: The scary sound of Aztec skull whistles https://caneuro.github.io/blog/2024/study-skullwhistle/ Habt Ihr Feedback? Anregungen? Wir freuen uns, von Euch zu hören: WhatsApp (https://wa.me/491746744240) oder iq@br.de.

Ist das der größte Schatz des Sonnensystems? - Riesige Diamanten auf Merkur entdeckt | Kilometerdicke Diamant-Schicht auf Merkur
Lieblingspodcast 2024 | #4 Wenig Zeit - trotzdem neugierig? Hier ist Euer Podcast Update für alles, was Ihr zu aktueller Forschung wissen müsst. Kurz, relevant und überraschend. Das Thema in dieser Podcast Folge: Hoher Druck, hohe Temperaturen und ein bisschen Schwefel: Das wäre nötig, damit auf Merkur Diamanten entstehen. Und all das ist auch da auf Merkur, daher vermuten Forscher, dass auch die Diamanten da sind - als kilometerdicke Schicht. https://www.nature.com/articles/s41467-024-49305-x Habt Ihr Feedback? Anregungen? Wir freuen uns, von Euch zu hören: WhatsApp oder iq@br.de























